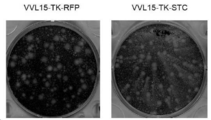

KR20210102196A - 암 치료를 위한 변형된 b5r 유전자를 갖는 종양용해 백시니아 바이러스 - Google Patents
암 치료를 위한 변형된 b5r 유전자를 갖는 종양용해 백시니아 바이러스 Download PDFInfo
- Publication number
- KR20210102196A KR20210102196A KR1020217013839A KR20217013839A KR20210102196A KR 20210102196 A KR20210102196 A KR 20210102196A KR 1020217013839 A KR1020217013839 A KR 1020217013839A KR 20217013839 A KR20217013839 A KR 20217013839A KR 20210102196 A KR20210102196 A KR 20210102196A
- Authority
- KR
- South Korea
- Prior art keywords
- stc
- vaccinia virus
- gene
- virus
- virus vector
- Prior art date
- Legal status (The legal status is an assumption and is not a legal conclusion. Google has not performed a legal analysis and makes no representation as to the accuracy of the status listed.)
- Pending
Links
- 241000700618 Vaccinia virus Species 0.000 title claims abstract description 126
- 238000011282 treatment Methods 0.000 title claims abstract description 42
- 108090000623 proteins and genes Proteins 0.000 title claims description 101
- 206010028980 Neoplasm Diseases 0.000 title claims description 89
- 201000011510 cancer Diseases 0.000 title claims description 29
- 230000000174 oncolytic effect Effects 0.000 title description 3
- 150000007523 nucleic acids Chemical group 0.000 claims abstract description 83
- 108091028043 Nucleic acid sequence Proteins 0.000 claims abstract description 63
- 239000013598 vector Substances 0.000 claims abstract description 57
- 238000000034 method Methods 0.000 claims abstract description 27
- 239000000203 mixture Substances 0.000 claims abstract description 27
- 101150003725 TK gene Proteins 0.000 claims abstract description 22
- 101100365087 Arabidopsis thaliana SCRA gene Proteins 0.000 claims abstract description 18
- 101150105073 SCR1 gene Proteins 0.000 claims abstract description 18
- 101100134054 Saccharomyces cerevisiae (strain ATCC 204508 / S288c) NTG1 gene Proteins 0.000 claims abstract description 18
- 101000668165 Homo sapiens RNA-binding motif, single-stranded-interacting protein 1 Proteins 0.000 claims abstract description 9
- 101000668170 Homo sapiens RNA-binding motif, single-stranded-interacting protein 2 Proteins 0.000 claims abstract description 9
- 102100039692 RNA-binding motif, single-stranded-interacting protein 1 Human genes 0.000 claims abstract description 9
- 102100039690 RNA-binding motif, single-stranded-interacting protein 2 Human genes 0.000 claims abstract description 9
- 102000004169 proteins and genes Human genes 0.000 claims description 55
- 101150035509 N1L gene Proteins 0.000 claims description 32
- 108010065805 Interleukin-12 Proteins 0.000 claims description 17
- 102000013462 Interleukin-12 Human genes 0.000 claims description 17
- 238000012217 deletion Methods 0.000 claims description 16
- 230000037430 deletion Effects 0.000 claims description 16
- 102000004127 Cytokines Human genes 0.000 claims description 15
- 108090000695 Cytokines Proteins 0.000 claims description 15
- 102000003812 Interleukin-15 Human genes 0.000 claims description 15
- 108090000172 Interleukin-15 Proteins 0.000 claims description 15
- 239000012634 fragment Substances 0.000 claims description 14
- 239000000872 buffer Substances 0.000 claims description 13
- 108010021625 Immunoglobulin Fragments Proteins 0.000 claims description 10
- 102000008394 Immunoglobulin Fragments Human genes 0.000 claims description 10
- 108010074108 interleukin-21 Proteins 0.000 claims description 10
- 102100040678 Programmed cell death protein 1 Human genes 0.000 claims description 9
- 108010074708 B7-H1 Antigen Proteins 0.000 claims description 5
- 102000008096 B7-H1 Antigen Human genes 0.000 claims description 5
- 108010017213 Granulocyte-Macrophage Colony-Stimulating Factor Proteins 0.000 claims description 5
- 102100039620 Granulocyte-macrophage colony-stimulating factor Human genes 0.000 claims description 5
- 229940076838 Immune checkpoint inhibitor Drugs 0.000 claims description 5
- 102000037984 Inhibitory immune checkpoint proteins Human genes 0.000 claims description 5
- 108091008026 Inhibitory immune checkpoint proteins Proteins 0.000 claims description 5
- 239000003085 diluting agent Substances 0.000 claims description 5
- 239000012274 immune-checkpoint protein inhibitor Substances 0.000 claims description 5
- 239000002671 adjuvant Substances 0.000 claims description 4
- 102000003675 cytokine receptors Human genes 0.000 claims description 4
- 108010057085 cytokine receptors Proteins 0.000 claims description 4
- 102000008203 CTLA-4 Antigen Human genes 0.000 claims description 3
- 108010021064 CTLA-4 Antigen Proteins 0.000 claims description 3
- 229940045513 CTLA4 antagonist Drugs 0.000 claims description 3
- 102100034458 Hepatitis A virus cellular receptor 2 Human genes 0.000 claims description 3
- 101710083479 Hepatitis A virus cellular receptor 2 homolog Proteins 0.000 claims description 3
- 102000006992 Interferon-alpha Human genes 0.000 claims description 3
- 108010047761 Interferon-alpha Proteins 0.000 claims description 3
- 102000003810 Interleukin-18 Human genes 0.000 claims description 3
- 108090000171 Interleukin-18 Proteins 0.000 claims description 3
- 108010002350 Interleukin-2 Proteins 0.000 claims description 3
- 102000000588 Interleukin-2 Human genes 0.000 claims description 3
- 108010002586 Interleukin-7 Proteins 0.000 claims description 3
- 102100021592 Interleukin-7 Human genes 0.000 claims description 3
- 229940126547 T-cell immunoglobulin mucin-3 Drugs 0.000 claims description 3
- -1 antibodies Proteins 0.000 claims description 3
- OHDXDNUPVVYWOV-UHFFFAOYSA-N n-methyl-1-(2-naphthalen-1-ylsulfanylphenyl)methanamine Chemical compound CNCC1=CC=CC=C1SC1=CC=CC2=CC=CC=C12 OHDXDNUPVVYWOV-UHFFFAOYSA-N 0.000 claims description 3
- 102100030703 Interleukin-22 Human genes 0.000 claims 1
- 206010046865 Vaccinia virus infection Diseases 0.000 abstract description 5
- 208000007089 vaccinia Diseases 0.000 abstract description 5
- 239000013603 viral vector Substances 0.000 abstract description 2
- 241000700605 Viruses Species 0.000 description 172
- 238000013127 simulated treatment comparison Methods 0.000 description 120
- 210000004027 cell Anatomy 0.000 description 119
- 108020004414 DNA Proteins 0.000 description 70
- 108020004440 Thymidine kinase Proteins 0.000 description 67
- 102000006601 Thymidine Kinase Human genes 0.000 description 66
- 108010054624 red fluorescent protein Proteins 0.000 description 65
- 108010076504 Protein Sorting Signals Proteins 0.000 description 51
- 108090000765 processed proteins & peptides Proteins 0.000 description 40
- 102000004196 processed proteins & peptides Human genes 0.000 description 39
- 229920001184 polypeptide Polymers 0.000 description 38
- 239000013605 shuttle vector Substances 0.000 description 37
- 150000001413 amino acids Chemical group 0.000 description 29
- 230000002441 reversible effect Effects 0.000 description 29
- 239000007924 injection Substances 0.000 description 28
- 238000002347 injection Methods 0.000 description 28
- 241000699670 Mus sp. Species 0.000 description 27
- 208000015181 infectious disease Diseases 0.000 description 25
- 101001010620 Mus musculus Interleukin-21 Proteins 0.000 description 24
- 101150073111 NPH1 gene Proteins 0.000 description 21
- 101100459380 Vaccinia virus (strain Western Reserve) VACWR028 gene Proteins 0.000 description 21
- 125000000539 amino acid group Chemical group 0.000 description 21
- 238000003780 insertion Methods 0.000 description 21
- 230000037431 insertion Effects 0.000 description 21
- 108020004707 nucleic acids Proteins 0.000 description 19
- 102000039446 nucleic acids Human genes 0.000 description 19
- 230000003612 virological effect Effects 0.000 description 18
- 230000000259 anti-tumor effect Effects 0.000 description 17
- 210000005220 cytoplasmic tail Anatomy 0.000 description 16
- 230000006801 homologous recombination Effects 0.000 description 16
- 238000002744 homologous recombination Methods 0.000 description 16
- 101001010621 Homo sapiens Interleukin-21 Proteins 0.000 description 15
- 229940117681 interleukin-12 Drugs 0.000 description 13
- 230000036961 partial effect Effects 0.000 description 13
- 238000004519 manufacturing process Methods 0.000 description 12
- 206010058467 Lung neoplasm malignant Diseases 0.000 description 11
- 206010061902 Pancreatic neoplasm Diseases 0.000 description 11
- 201000005202 lung cancer Diseases 0.000 description 11
- 208000020816 lung neoplasm Diseases 0.000 description 11
- 244000309459 oncolytic virus Species 0.000 description 11
- 201000002528 pancreatic cancer Diseases 0.000 description 11
- 108091008146 restriction endonucleases Proteins 0.000 description 11
- 108060003951 Immunoglobulin Proteins 0.000 description 10
- 241000699666 Mus <mouse, genus> Species 0.000 description 10
- 230000015572 biosynthetic process Effects 0.000 description 10
- 239000006143 cell culture medium Substances 0.000 description 10
- 102000018358 immunoglobulin Human genes 0.000 description 10
- 108010017391 lysylvaline Proteins 0.000 description 10
- 208000008443 pancreatic carcinoma Diseases 0.000 description 10
- 210000004899 c-terminal region Anatomy 0.000 description 9
- YKLIKGKUANLGSB-HNNXBMFYSA-N idelalisib Chemical compound C1([C@@H](NC=2[C]3N=CN=C3N=CN=2)CC)=NC2=CC=CC(F)=C2C(=O)N1C1=CC=CC=C1 YKLIKGKUANLGSB-HNNXBMFYSA-N 0.000 description 9
- 229960003445 idelalisib Drugs 0.000 description 9
- 208000015486 malignant pancreatic neoplasm Diseases 0.000 description 9
- 102000009109 Fc receptors Human genes 0.000 description 8
- 108010087819 Fc receptors Proteins 0.000 description 8
- 102100030704 Interleukin-21 Human genes 0.000 description 8
- 125000003275 alpha amino acid group Chemical group 0.000 description 8
- 238000000338 in vitro Methods 0.000 description 8
- 239000000047 product Substances 0.000 description 8
- 230000004083 survival effect Effects 0.000 description 8
- 230000003442 weekly effect Effects 0.000 description 8
- POTCZYQVVNXUIG-BQBZGAKWSA-N Asp-Gly-Pro Chemical compound OC(=O)C[C@H](N)C(=O)NCC(=O)N1CCC[C@H]1C(O)=O POTCZYQVVNXUIG-BQBZGAKWSA-N 0.000 description 7
- WRODMZBHNNPRLN-SRVKXCTJSA-N Lys-Leu-Ser Chemical compound [H]N[C@@H](CCCCN)C(=O)N[C@@H](CC(C)C)C(=O)N[C@@H](CO)C(O)=O WRODMZBHNNPRLN-SRVKXCTJSA-N 0.000 description 7
- 241001465754 Metazoa Species 0.000 description 7
- 239000006166 lysate Substances 0.000 description 7
- 230000004048 modification Effects 0.000 description 7
- 238000012986 modification Methods 0.000 description 7
- 239000002773 nucleotide Substances 0.000 description 7
- 125000003729 nucleotide group Chemical group 0.000 description 7
- 239000013612 plasmid Substances 0.000 description 7
- 238000000746 purification Methods 0.000 description 7
- 230000006798 recombination Effects 0.000 description 7
- 238000005215 recombination Methods 0.000 description 7
- 238000007920 subcutaneous administration Methods 0.000 description 7
- 239000000126 substance Substances 0.000 description 7
- 230000001225 therapeutic effect Effects 0.000 description 7
- 238000002965 ELISA Methods 0.000 description 6
- 101000834898 Homo sapiens Alpha-synuclein Proteins 0.000 description 6
- 101000611936 Homo sapiens Programmed cell death protein 1 Proteins 0.000 description 6
- 101000652359 Homo sapiens Spermatogenesis-associated protein 2 Proteins 0.000 description 6
- ULEBESPCVWBNIF-BYPYZUCNSA-N L-arginine amide Chemical compound NC(=O)[C@@H](N)CCCNC(N)=N ULEBESPCVWBNIF-BYPYZUCNSA-N 0.000 description 6
- 241000699673 Mesocricetus auratus Species 0.000 description 6
- 108010002311 N-glycylglutamic acid Proteins 0.000 description 6
- HDOVUKNUBWVHOX-QMMMGPOBSA-N Valacyclovir Chemical compound N1C(N)=NC(=O)C2=C1N(COCCOC(=O)[C@@H](N)C(C)C)C=N2 HDOVUKNUBWVHOX-QMMMGPOBSA-N 0.000 description 6
- 108010047857 aspartylglycine Proteins 0.000 description 6
- 108010092854 aspartyllysine Proteins 0.000 description 6
- 210000004369 blood Anatomy 0.000 description 6
- 239000008280 blood Substances 0.000 description 6
- 239000003814 drug Substances 0.000 description 6
- 238000001415 gene therapy Methods 0.000 description 6
- 230000002458 infectious effect Effects 0.000 description 6
- 239000003112 inhibitor Substances 0.000 description 6
- 239000007928 intraperitoneal injection Substances 0.000 description 6
- 230000001404 mediated effect Effects 0.000 description 6
- 239000000243 solution Substances 0.000 description 6
- 210000004881 tumor cell Anatomy 0.000 description 6
- 230000004614 tumor growth Effects 0.000 description 6
- 238000011144 upstream manufacturing Methods 0.000 description 6
- 108010073969 valyllysine Proteins 0.000 description 6
- 206010009944 Colon cancer Diseases 0.000 description 5
- IDEODOAVGCMUQV-GUBZILKMSA-N Glu-Ser-Leu Chemical compound [H]N[C@@H](CCC(O)=O)C(=O)N[C@@H](CO)C(=O)N[C@@H](CC(C)C)C(O)=O IDEODOAVGCMUQV-GUBZILKMSA-N 0.000 description 5
- PEDCQBHIVMGVHV-UHFFFAOYSA-N Glycerine Chemical compound OCC(O)CO PEDCQBHIVMGVHV-UHFFFAOYSA-N 0.000 description 5
- HXIDVIFHRYRXLZ-NAKRPEOUSA-N Ile-Ser-Val Chemical compound CC[C@H](C)[C@@H](C(=O)N[C@@H](CO)C(=O)N[C@@H](C(C)C)C(=O)O)N HXIDVIFHRYRXLZ-NAKRPEOUSA-N 0.000 description 5
- XVZCXCTYGHPNEM-UHFFFAOYSA-N Leu-Leu-Pro Natural products CC(C)CC(N)C(=O)NC(CC(C)C)C(=O)N1CCCC1C(O)=O XVZCXCTYGHPNEM-UHFFFAOYSA-N 0.000 description 5
- TUIOUEWKFFVNLH-DCAQKATOSA-N Leu-Val-Cys Chemical compound CC(C)C[C@H](N)C(=O)N[C@@H](C(C)C)C(=O)N[C@@H](CS)C(O)=O TUIOUEWKFFVNLH-DCAQKATOSA-N 0.000 description 5
- ABHIXYDMILIUKV-CIUDSAMLSA-N Lys-Asn-Asn Chemical compound [H]N[C@@H](CCCCN)C(=O)N[C@@H](CC(N)=O)C(=O)N[C@@H](CC(N)=O)C(O)=O ABHIXYDMILIUKV-CIUDSAMLSA-N 0.000 description 5
- KNCJWSPMTFFJII-ZLUOBGJFSA-N Ser-Cys-Asp Chemical compound [H]N[C@@H](CO)C(=O)N[C@@H](CS)C(=O)N[C@@H](CC(O)=O)C(O)=O KNCJWSPMTFFJII-ZLUOBGJFSA-N 0.000 description 5
- 108020005202 Viral DNA Proteins 0.000 description 5
- 230000005809 anti-tumor immunity Effects 0.000 description 5
- 108010093581 aspartyl-proline Proteins 0.000 description 5
- 238000010276 construction Methods 0.000 description 5
- 239000013078 crystal Substances 0.000 description 5
- 230000002950 deficient Effects 0.000 description 5
- 230000000694 effects Effects 0.000 description 5
- 238000001727 in vivo Methods 0.000 description 5
- 238000007912 intraperitoneal administration Methods 0.000 description 5
- 238000001990 intravenous administration Methods 0.000 description 5
- 239000002777 nucleoside Substances 0.000 description 5
- 238000011275 oncology therapy Methods 0.000 description 5
- 230000010076 replication Effects 0.000 description 5
- 108010069117 seryl-lysyl-aspartic acid Proteins 0.000 description 5
- 108010048397 seryl-lysyl-leucine Proteins 0.000 description 5
- 108091032973 (ribonucleotides)n+m Proteins 0.000 description 4
- UFAQGGZUXVLONR-AVGNSLFASA-N Asp-Gln-Tyr Chemical compound C1=CC(=CC=C1C[C@@H](C(=O)O)NC(=O)[C@H](CCC(=O)N)NC(=O)[C@H](CC(=O)O)N)O UFAQGGZUXVLONR-AVGNSLFASA-N 0.000 description 4
- XDGBFDYXZCMYEX-NUMRIWBASA-N Asp-Glu-Thr Chemical compound C[C@H]([C@@H](C(=O)O)NC(=O)[C@H](CCC(=O)O)NC(=O)[C@H](CC(=O)O)N)O XDGBFDYXZCMYEX-NUMRIWBASA-N 0.000 description 4
- UMHUHHJMEXNSIV-CIUDSAMLSA-N Asp-Leu-Ser Chemical compound OC[C@@H](C(O)=O)NC(=O)[C@H](CC(C)C)NC(=O)[C@@H](N)CC(O)=O UMHUHHJMEXNSIV-CIUDSAMLSA-N 0.000 description 4
- 102100021277 Beta-secretase 2 Human genes 0.000 description 4
- 101710150190 Beta-secretase 2 Proteins 0.000 description 4
- 238000011740 C57BL/6 mouse Methods 0.000 description 4
- 241000699800 Cricetinae Species 0.000 description 4
- MHYHLWUGWUBUHF-GUBZILKMSA-N Cys-Val-Arg Chemical compound CC(C)[C@@H](C(=O)N[C@@H](CCCN=C(N)N)C(=O)O)NC(=O)[C@H](CS)N MHYHLWUGWUBUHF-GUBZILKMSA-N 0.000 description 4
- KDXKFBSNIJYNNR-YVNDNENWSA-N Gln-Glu-Ile Chemical compound [H]N[C@@H](CCC(N)=O)C(=O)N[C@@H](CCC(O)=O)C(=O)N[C@@H]([C@@H](C)CC)C(O)=O KDXKFBSNIJYNNR-YVNDNENWSA-N 0.000 description 4
- YJRSIJZUIUANHO-NAKRPEOUSA-N Ile-Val-Ala Chemical compound CC[C@H](C)[C@@H](C(=O)N[C@@H](C(C)C)C(=O)N[C@@H](C)C(=O)O)N YJRSIJZUIUANHO-NAKRPEOUSA-N 0.000 description 4
- WCTCIIAGNMFYAO-DCAQKATOSA-N Leu-Cys-Val Chemical compound [H]N[C@@H](CC(C)C)C(=O)N[C@@H](CS)C(=O)N[C@@H](C(C)C)C(O)=O WCTCIIAGNMFYAO-DCAQKATOSA-N 0.000 description 4
- WMIOEVKKYIMVKI-DCAQKATOSA-N Leu-Pro-Ala Chemical compound [H]N[C@@H](CC(C)C)C(=O)N1CCC[C@H]1C(=O)N[C@@H](C)C(O)=O WMIOEVKKYIMVKI-DCAQKATOSA-N 0.000 description 4
- LJBVRCDPWOJOEK-PPCPHDFISA-N Leu-Thr-Ile Chemical compound [H]N[C@@H](CC(C)C)C(=O)N[C@@H]([C@@H](C)O)C(=O)N[C@@H]([C@@H](C)CC)C(O)=O LJBVRCDPWOJOEK-PPCPHDFISA-N 0.000 description 4
- GKFNXYMAMKJSKD-NHCYSSNCSA-N Lys-Asp-Val Chemical compound [H]N[C@@H](CCCCN)C(=O)N[C@@H](CC(O)=O)C(=O)N[C@@H](C(C)C)C(O)=O GKFNXYMAMKJSKD-NHCYSSNCSA-N 0.000 description 4
- AIRZWUMAHCDDHR-KKUMJFAQSA-N Lys-Leu-Leu Chemical compound [H]N[C@@H](CCCCN)C(=O)N[C@@H](CC(C)C)C(=O)N[C@@H](CC(C)C)C(O)=O AIRZWUMAHCDDHR-KKUMJFAQSA-N 0.000 description 4
- TWPCWKVOZDUYAA-KKUMJFAQSA-N Lys-Phe-Asp Chemical compound [H]N[C@@H](CCCCN)C(=O)N[C@@H](CC1=CC=CC=C1)C(=O)N[C@@H](CC(O)=O)C(O)=O TWPCWKVOZDUYAA-KKUMJFAQSA-N 0.000 description 4
- BPDXWKVZNCKUGG-BZSNNMDCSA-N Lys-Phe-His Chemical compound C1=CC=C(C=C1)C[C@@H](C(=O)N[C@@H](CC2=CN=CN2)C(=O)O)NC(=O)[C@H](CCCCN)N BPDXWKVZNCKUGG-BZSNNMDCSA-N 0.000 description 4
- BMHIFARYXOJDLD-WPRPVWTQSA-N Met-Gly-Val Chemical compound [H]N[C@@H](CCSC)C(=O)NCC(=O)N[C@@H](C(C)C)C(O)=O BMHIFARYXOJDLD-WPRPVWTQSA-N 0.000 description 4
- LCPUWQLULVXROY-RHYQMDGZSA-N Met-Lys-Thr Chemical compound CSCC[C@H](N)C(=O)N[C@@H](CCCCN)C(=O)N[C@@H]([C@@H](C)O)C(O)=O LCPUWQLULVXROY-RHYQMDGZSA-N 0.000 description 4
- 108091034117 Oligonucleotide Proteins 0.000 description 4
- 108700026244 Open Reading Frames Proteins 0.000 description 4
- OOZJHTXCLJUODH-QXEWZRGKSA-N Pro-Val-Asp Chemical compound OC(=O)C[C@@H](C(O)=O)NC(=O)[C@H](C(C)C)NC(=O)[C@@H]1CCCN1 OOZJHTXCLJUODH-QXEWZRGKSA-N 0.000 description 4
- QGXCWPNQVCYJEL-NUMRIWBASA-N Thr-Asn-Glu Chemical compound [H]N[C@@H]([C@@H](C)O)C(=O)N[C@@H](CC(N)=O)C(=O)N[C@@H](CCC(O)=O)C(O)=O QGXCWPNQVCYJEL-NUMRIWBASA-N 0.000 description 4
- IQFYYKKMVGJFEH-XLPZGREQSA-N Thymidine Chemical compound O=C1NC(=O)C(C)=CN1[C@@H]1O[C@H](CO)[C@@H](O)C1 IQFYYKKMVGJFEH-XLPZGREQSA-N 0.000 description 4
- AAOPYWQQBXHINJ-DZKIICNBSA-N Val-Gln-Tyr Chemical compound CC(C)[C@@H](C(=O)N[C@@H](CCC(=O)N)C(=O)N[C@@H](CC1=CC=C(C=C1)O)C(=O)O)N AAOPYWQQBXHINJ-DZKIICNBSA-N 0.000 description 4
- LCHZBEUVGAVMKS-RHYQMDGZSA-N Val-Thr-Leu Chemical compound CC(C)C[C@H](NC(=O)[C@@H](NC(=O)[C@@H](N)C(C)C)[C@@H](C)O)C(O)=O LCHZBEUVGAVMKS-RHYQMDGZSA-N 0.000 description 4
- IECQJCJNPJVUSB-IHRRRGAJSA-N Val-Tyr-Ser Chemical compound CC(C)[C@H](N)C(=O)N[C@@H](Cc1ccc(O)cc1)C(=O)N[C@@H](CO)C(O)=O IECQJCJNPJVUSB-IHRRRGAJSA-N 0.000 description 4
- OIRDTQYFTABQOQ-KQYNXXCUSA-N adenosine Chemical compound C1=NC=2C(N)=NC=NC=2N1[C@@H]1O[C@H](CO)[C@@H](O)[C@H]1O OIRDTQYFTABQOQ-KQYNXXCUSA-N 0.000 description 4
- 239000000427 antigen Substances 0.000 description 4
- 108091007433 antigens Proteins 0.000 description 4
- 102000036639 antigens Human genes 0.000 description 4
- 108010040443 aspartyl-aspartic acid Proteins 0.000 description 4
- 238000003556 assay Methods 0.000 description 4
- 208000029742 colonic neoplasm Diseases 0.000 description 4
- 230000000295 complement effect Effects 0.000 description 4
- 238000012790 confirmation Methods 0.000 description 4
- 231100000135 cytotoxicity Toxicity 0.000 description 4
- 230000003013 cytotoxicity Effects 0.000 description 4
- 230000006870 function Effects 0.000 description 4
- 238000010253 intravenous injection Methods 0.000 description 4
- 108010078274 isoleucylvaline Proteins 0.000 description 4
- 210000002540 macrophage Anatomy 0.000 description 4
- 238000005259 measurement Methods 0.000 description 4
- 230000035772 mutation Effects 0.000 description 4
- 238000003305 oral gavage Methods 0.000 description 4
- 239000008188 pellet Substances 0.000 description 4
- 239000008194 pharmaceutical composition Substances 0.000 description 4
- 238000012163 sequencing technique Methods 0.000 description 4
- 238000012360 testing method Methods 0.000 description 4
- 238000002560 therapeutic procedure Methods 0.000 description 4
- 210000001519 tissue Anatomy 0.000 description 4
- 239000003981 vehicle Substances 0.000 description 4
- NHBKXEKEPDILRR-UHFFFAOYSA-N 2,3-bis(butanoylsulfanyl)propyl butanoate Chemical compound CCCC(=O)OCC(SC(=O)CCC)CSC(=O)CCC NHBKXEKEPDILRR-UHFFFAOYSA-N 0.000 description 3
- ZDTFMPXQUSBYRL-UUOKFMHZSA-N 2-Aminoadenosine Chemical compound C12=NC(N)=NC(N)=C2N=CN1[C@@H]1O[C@H](CO)[C@@H](O)[C@H]1O ZDTFMPXQUSBYRL-UUOKFMHZSA-N 0.000 description 3
- QKNYBSVHEMOAJP-UHFFFAOYSA-N 2-amino-2-(hydroxymethyl)propane-1,3-diol;hydron;chloride Chemical compound Cl.OCC(N)(CO)CO QKNYBSVHEMOAJP-UHFFFAOYSA-N 0.000 description 3
- GWFSQQNGMPGBEF-GHCJXIJMSA-N Ala-Asp-Ile Chemical compound CC[C@H](C)[C@@H](C(=O)O)NC(=O)[C@H](CC(=O)O)NC(=O)[C@H](C)N GWFSQQNGMPGBEF-GHCJXIJMSA-N 0.000 description 3
- AWZKCUCQJNTBAD-SRVKXCTJSA-N Ala-Leu-Lys Chemical compound C[C@H](N)C(=O)N[C@@H](CC(C)C)C(=O)N[C@H](C(O)=O)CCCCN AWZKCUCQJNTBAD-SRVKXCTJSA-N 0.000 description 3
- VCSABYLVNWQYQE-SRVKXCTJSA-N Ala-Lys-Lys Chemical compound NCCCC[C@H](NC(=O)[C@@H](N)C)C(=O)N[C@@H](CCCCN)C(O)=O VCSABYLVNWQYQE-SRVKXCTJSA-N 0.000 description 3
- VCSABYLVNWQYQE-UHFFFAOYSA-N Ala-Lys-Lys Natural products NCCCCC(NC(=O)C(N)C)C(=O)NC(CCCCN)C(O)=O VCSABYLVNWQYQE-UHFFFAOYSA-N 0.000 description 3
- WQKAQKZRDIZYNV-VZFHVOOUSA-N Ala-Ser-Thr Chemical compound [H]N[C@@H](C)C(=O)N[C@@H](CO)C(=O)N[C@@H]([C@@H](C)O)C(O)=O WQKAQKZRDIZYNV-VZFHVOOUSA-N 0.000 description 3
- CREYEAPXISDKSB-FQPOAREZSA-N Ala-Thr-Tyr Chemical compound [H]N[C@@H](C)C(=O)N[C@@H]([C@@H](C)O)C(=O)N[C@@H](CC1=CC=C(O)C=C1)C(O)=O CREYEAPXISDKSB-FQPOAREZSA-N 0.000 description 3
- VIINVRPKMUZYOI-DCAQKATOSA-N Arg-Met-Glu Chemical compound [H]N[C@@H](CCCNC(N)=N)C(=O)N[C@@H](CCSC)C(=O)N[C@@H](CCC(O)=O)C(O)=O VIINVRPKMUZYOI-DCAQKATOSA-N 0.000 description 3
- KZXPVYVSHUJCEO-ULQDDVLXSA-N Arg-Phe-Lys Chemical compound NC(=N)NCCC[C@H](N)C(=O)N[C@H](C(=O)N[C@@H](CCCCN)C(O)=O)CC1=CC=CC=C1 KZXPVYVSHUJCEO-ULQDDVLXSA-N 0.000 description 3
- OWSMKCJUBAPHED-JYJNAYRXSA-N Arg-Pro-Tyr Chemical compound NC(N)=NCCC[C@H](N)C(=O)N1CCC[C@H]1C(=O)N[C@H](C(O)=O)CC1=CC=C(O)C=C1 OWSMKCJUBAPHED-JYJNAYRXSA-N 0.000 description 3
- HCAUEJAQCXVQQM-ACZMJKKPSA-N Asn-Glu-Asp Chemical compound [H]N[C@@H](CC(N)=O)C(=O)N[C@@H](CCC(O)=O)C(=O)N[C@@H](CC(O)=O)C(O)=O HCAUEJAQCXVQQM-ACZMJKKPSA-N 0.000 description 3
- GWNMUVANAWDZTI-YUMQZZPRSA-N Asn-Gly-His Chemical compound C1=C(NC=N1)C[C@@H](C(=O)O)NC(=O)CNC(=O)[C@H](CC(=O)N)N GWNMUVANAWDZTI-YUMQZZPRSA-N 0.000 description 3
- BCADFFUQHIMQAA-KKHAAJSZSA-N Asn-Thr-Val Chemical compound [H]N[C@@H](CC(N)=O)C(=O)N[C@@H]([C@@H](C)O)C(=O)N[C@@H](C(C)C)C(O)=O BCADFFUQHIMQAA-KKHAAJSZSA-N 0.000 description 3
- VPPXTHJNTYDNFJ-CIUDSAMLSA-N Asp-Ala-Lys Chemical compound C[C@@H](C(=O)N[C@@H](CCCCN)C(=O)O)NC(=O)[C@H](CC(=O)O)N VPPXTHJNTYDNFJ-CIUDSAMLSA-N 0.000 description 3
- WSGVTKZFVJSJOG-RCOVLWMOSA-N Asp-Gly-Val Chemical compound [H]N[C@@H](CC(O)=O)C(=O)NCC(=O)N[C@@H](C(C)C)C(O)=O WSGVTKZFVJSJOG-RCOVLWMOSA-N 0.000 description 3
- BJDHEININLSZOT-KKUMJFAQSA-N Asp-Tyr-Lys Chemical compound [H]N[C@@H](CC(O)=O)C(=O)N[C@@H](CC1=CC=C(O)C=C1)C(=O)N[C@@H](CCCCN)C(O)=O BJDHEININLSZOT-KKUMJFAQSA-N 0.000 description 3
- 108091033409 CRISPR Proteins 0.000 description 3
- 101100315624 Caenorhabditis elegans tyr-1 gene Proteins 0.000 description 3
- 108010051219 Cre recombinase Proteins 0.000 description 3
- 102000053602 DNA Human genes 0.000 description 3
- KKCUFHUTMKQQCF-SRVKXCTJSA-N Glu-Arg-Leu Chemical compound [H]N[C@@H](CCC(O)=O)C(=O)N[C@@H](CCCNC(N)=N)C(=O)N[C@@H](CC(C)C)C(O)=O KKCUFHUTMKQQCF-SRVKXCTJSA-N 0.000 description 3
- SRZLHYPAOXBBSB-HJGDQZAQSA-N Glu-Arg-Thr Chemical compound [H]N[C@@H](CCC(O)=O)C(=O)N[C@@H](CCCNC(N)=N)C(=O)N[C@@H]([C@@H](C)O)C(O)=O SRZLHYPAOXBBSB-HJGDQZAQSA-N 0.000 description 3
- DSPQRJXOIXHOHK-WDSKDSINSA-N Glu-Asp-Gly Chemical compound OC(=O)CC[C@H](N)C(=O)N[C@@H](CC(O)=O)C(=O)NCC(O)=O DSPQRJXOIXHOHK-WDSKDSINSA-N 0.000 description 3
- HUFCEIHAFNVSNR-IHRRRGAJSA-N Glu-Gln-Tyr Chemical compound OC(=O)CC[C@H](N)C(=O)N[C@@H](CCC(N)=O)C(=O)N[C@H](C(O)=O)CC1=CC=C(O)C=C1 HUFCEIHAFNVSNR-IHRRRGAJSA-N 0.000 description 3
- PXXGVUVQWQGGIG-YUMQZZPRSA-N Glu-Gly-Arg Chemical compound OC(=O)CC[C@H](N)C(=O)NCC(=O)N[C@H](C(O)=O)CCCN=C(N)N PXXGVUVQWQGGIG-YUMQZZPRSA-N 0.000 description 3
- CAVMESABQIKFKT-IUCAKERBSA-N Glu-Gly-His Chemical compound C1=C(NC=N1)C[C@@H](C(=O)O)NC(=O)CNC(=O)[C@H](CCC(=O)O)N CAVMESABQIKFKT-IUCAKERBSA-N 0.000 description 3
- JDUKCSSHWNIQQZ-IHRRRGAJSA-N Glu-Phe-Glu Chemical compound [H]N[C@@H](CCC(O)=O)C(=O)N[C@@H](CC1=CC=CC=C1)C(=O)N[C@@H](CCC(O)=O)C(O)=O JDUKCSSHWNIQQZ-IHRRRGAJSA-N 0.000 description 3
- CHDWDBPJOZVZSE-KKUMJFAQSA-N Glu-Phe-Met Chemical compound [H]N[C@@H](CCC(O)=O)C(=O)N[C@@H](CC1=CC=CC=C1)C(=O)N[C@@H](CCSC)C(O)=O CHDWDBPJOZVZSE-KKUMJFAQSA-N 0.000 description 3
- KKBWDNZXYLGJEY-UHFFFAOYSA-N Gly-Arg-Pro Natural products NCC(=O)NC(CCNC(=N)N)C(=O)N1CCCC1C(=O)O KKBWDNZXYLGJEY-UHFFFAOYSA-N 0.000 description 3
- SABZDFAAOJATBR-QWRGUYRKSA-N Gly-Cys-Phe Chemical compound [H]NCC(=O)N[C@@H](CS)C(=O)N[C@@H](CC1=CC=CC=C1)C(O)=O SABZDFAAOJATBR-QWRGUYRKSA-N 0.000 description 3
- XTQFHTHIAKKCTM-YFKPBYRVSA-N Gly-Glu-Gly Chemical compound NCC(=O)N[C@@H](CCC(O)=O)C(=O)NCC(O)=O XTQFHTHIAKKCTM-YFKPBYRVSA-N 0.000 description 3
- PDAWDNVHMUKWJR-ZETCQYMHSA-N Gly-Gly-His Chemical compound NCC(=O)NCC(=O)N[C@H](C(O)=O)CC1=CNC=N1 PDAWDNVHMUKWJR-ZETCQYMHSA-N 0.000 description 3
- YLEIWGJJBFBFHC-KBPBESRZSA-N Gly-Phe-Lys Chemical compound NCCCC[C@@H](C(O)=O)NC(=O)[C@@H](NC(=O)CN)CC1=CC=CC=C1 YLEIWGJJBFBFHC-KBPBESRZSA-N 0.000 description 3
- HFPVRZWORNJRRC-UWVGGRQHSA-N Gly-Pro-Leu Chemical compound CC(C)C[C@@H](C(O)=O)NC(=O)[C@@H]1CCCN1C(=O)CN HFPVRZWORNJRRC-UWVGGRQHSA-N 0.000 description 3
- POJJAZJHBGXEGM-YUMQZZPRSA-N Gly-Ser-Lys Chemical compound C(CCN)C[C@@H](C(=O)O)NC(=O)[C@H](CO)NC(=O)CN POJJAZJHBGXEGM-YUMQZZPRSA-N 0.000 description 3
- CUVBTVWFVIIDOC-YEPSODPASA-N Gly-Thr-Val Chemical compound CC(C)[C@@H](C(O)=O)NC(=O)[C@H]([C@@H](C)O)NC(=O)CN CUVBTVWFVIIDOC-YEPSODPASA-N 0.000 description 3
- GWCJMBNBFYBQCV-XPUUQOCRSA-N Gly-Val-Ala Chemical compound NCC(=O)N[C@@H](C(C)C)C(=O)N[C@@H](C)C(O)=O GWCJMBNBFYBQCV-XPUUQOCRSA-N 0.000 description 3
- 102000003886 Glycoproteins Human genes 0.000 description 3
- 108090000288 Glycoproteins Proteins 0.000 description 3
- RVKIPWVMZANZLI-UHFFFAOYSA-N H-Lys-Trp-OH Natural products C1=CC=C2C(CC(NC(=O)C(N)CCCCN)C(O)=O)=CNC2=C1 RVKIPWVMZANZLI-UHFFFAOYSA-N 0.000 description 3
- PMWSGVRIMIFXQH-KKUMJFAQSA-N His-His-Leu Chemical compound C([C@@H](C(=O)N[C@@H](CC(C)C)C(O)=O)NC(=O)[C@@H](N)CC=1NC=NC=1)C1=CN=CN1 PMWSGVRIMIFXQH-KKUMJFAQSA-N 0.000 description 3
- MLZVJIREOKTDAR-SIGLWIIPSA-N His-Ile-Ile Chemical compound [H]N[C@@H](CC1=CNC=N1)C(=O)N[C@@H]([C@@H](C)CC)C(=O)N[C@@H]([C@@H](C)CC)C(O)=O MLZVJIREOKTDAR-SIGLWIIPSA-N 0.000 description 3
- MTFVYKQRLXYAQN-LAEOZQHASA-N Ile-Glu-Gly Chemical compound [H]N[C@@H]([C@@H](C)CC)C(=O)N[C@@H](CCC(O)=O)C(=O)NCC(O)=O MTFVYKQRLXYAQN-LAEOZQHASA-N 0.000 description 3
- VOBYAKCXGQQFLR-LSJOCFKGSA-N Ile-Gly-Val Chemical compound CC[C@H](C)[C@H](N)C(=O)NCC(=O)N[C@@H](C(C)C)C(O)=O VOBYAKCXGQQFLR-LSJOCFKGSA-N 0.000 description 3
- ZUWSVOYKBCHLRR-MGHWNKPDSA-N Ile-Tyr-Lys Chemical compound CC[C@H](C)[C@@H](C(=O)N[C@@H](CC1=CC=C(C=C1)O)C(=O)N[C@@H](CCCCN)C(=O)O)N ZUWSVOYKBCHLRR-MGHWNKPDSA-N 0.000 description 3
- HODVZHLJUUWPKY-STECZYCISA-N Ile-Tyr-Met Chemical compound CSCC[C@@H](C(O)=O)NC(=O)[C@@H](NC(=O)[C@@H](N)[C@@H](C)CC)CC1=CC=C(O)C=C1 HODVZHLJUUWPKY-STECZYCISA-N 0.000 description 3
- 102000037982 Immune checkpoint proteins Human genes 0.000 description 3
- 108091008036 Immune checkpoint proteins Proteins 0.000 description 3
- 238000010824 Kaplan-Meier survival analysis Methods 0.000 description 3
- KTFHTMHHKXUYPW-ZPFDUUQYSA-N Leu-Asp-Ile Chemical compound [H]N[C@@H](CC(C)C)C(=O)N[C@@H](CC(O)=O)C(=O)N[C@@H]([C@@H](C)CC)C(O)=O KTFHTMHHKXUYPW-ZPFDUUQYSA-N 0.000 description 3
- ZYLJULGXQDNXDK-GUBZILKMSA-N Leu-Gln-Asp Chemical compound [H]N[C@@H](CC(C)C)C(=O)N[C@@H](CCC(N)=O)C(=O)N[C@@H](CC(O)=O)C(O)=O ZYLJULGXQDNXDK-GUBZILKMSA-N 0.000 description 3
- RZXLZBIUTDQHJQ-SRVKXCTJSA-N Leu-Lys-Asp Chemical compound [H]N[C@@H](CC(C)C)C(=O)N[C@@H](CCCCN)C(=O)N[C@@H](CC(O)=O)C(O)=O RZXLZBIUTDQHJQ-SRVKXCTJSA-N 0.000 description 3
- LVTJJOJKDCVZGP-QWRGUYRKSA-N Leu-Lys-Gly Chemical compound [H]N[C@@H](CC(C)C)C(=O)N[C@@H](CCCCN)C(=O)NCC(O)=O LVTJJOJKDCVZGP-QWRGUYRKSA-N 0.000 description 3
- UCBPDSYUVAAHCD-UWVGGRQHSA-N Leu-Pro-Gly Chemical compound CC(C)C[C@H](N)C(=O)N1CCC[C@H]1C(=O)NCC(O)=O UCBPDSYUVAAHCD-UWVGGRQHSA-N 0.000 description 3
- SBANPBVRHYIMRR-GARJFASQSA-N Leu-Ser-Pro Chemical compound CC(C)C[C@@H](C(=O)N[C@@H](CO)C(=O)N1CCC[C@@H]1C(=O)O)N SBANPBVRHYIMRR-GARJFASQSA-N 0.000 description 3
- SBANPBVRHYIMRR-UHFFFAOYSA-N Leu-Ser-Pro Natural products CC(C)CC(N)C(=O)NC(CO)C(=O)N1CCCC1C(O)=O SBANPBVRHYIMRR-UHFFFAOYSA-N 0.000 description 3
- GNLJXWBNLAIPEP-MELADBBJSA-N Lys-His-Pro Chemical compound C1C[C@@H](N(C1)C(=O)[C@H](CC2=CN=CN2)NC(=O)[C@H](CCCCN)N)C(=O)O GNLJXWBNLAIPEP-MELADBBJSA-N 0.000 description 3
- RBEATVHTWHTHTJ-KKUMJFAQSA-N Lys-Leu-Lys Chemical compound NCCCC[C@H](N)C(=O)N[C@@H](CC(C)C)C(=O)N[C@@H](CCCCN)C(O)=O RBEATVHTWHTHTJ-KKUMJFAQSA-N 0.000 description 3
- PLDJDCJLRCYPJB-VOAKCMCISA-N Lys-Lys-Thr Chemical compound [H]N[C@@H](CCCCN)C(=O)N[C@@H](CCCCN)C(=O)N[C@@H]([C@@H](C)O)C(O)=O PLDJDCJLRCYPJB-VOAKCMCISA-N 0.000 description 3
- WXHHTBVYQOSYSL-FXQIFTODSA-N Met-Ala-Ser Chemical compound CSCC[C@H](N)C(=O)N[C@@H](C)C(=O)N[C@@H](CO)C(O)=O WXHHTBVYQOSYSL-FXQIFTODSA-N 0.000 description 3
- UAPZLLPGGOOCRO-IHRRRGAJSA-N Met-Asn-Phe Chemical compound CSCC[C@@H](C(=O)N[C@@H](CC(=O)N)C(=O)N[C@@H](CC1=CC=CC=C1)C(=O)O)N UAPZLLPGGOOCRO-IHRRRGAJSA-N 0.000 description 3
- MHQXIBRPDKXDGZ-ZFWWWQNUSA-N Met-Gly-Trp Chemical compound C1=CC=C2C(C[C@H](NC(=O)CNC(=O)[C@@H](N)CCSC)C(O)=O)=CNC2=C1 MHQXIBRPDKXDGZ-ZFWWWQNUSA-N 0.000 description 3
- WUGMRIBZSVSJNP-UHFFFAOYSA-N N-L-alanyl-L-tryptophan Natural products C1=CC=C2C(CC(NC(=O)C(N)C)C(O)=O)=CNC2=C1 WUGMRIBZSVSJNP-UHFFFAOYSA-N 0.000 description 3
- 108010087066 N2-tryptophyllysine Proteins 0.000 description 3
- ABQFNJAFONNUTH-FHWLQOOXSA-N Phe-Gln-Tyr Chemical compound C1=CC=C(C=C1)C[C@@H](C(=O)N[C@@H](CCC(=O)N)C(=O)N[C@@H](CC2=CC=C(C=C2)O)C(=O)O)N ABQFNJAFONNUTH-FHWLQOOXSA-N 0.000 description 3
- KZRQONDKKJCAOL-DKIMLUQUSA-N Phe-Leu-Ile Chemical compound [H]N[C@@H](CC1=CC=CC=C1)C(=O)N[C@@H](CC(C)C)C(=O)N[C@@H]([C@@H](C)CC)C(O)=O KZRQONDKKJCAOL-DKIMLUQUSA-N 0.000 description 3
- SCKXGHWQPPURGT-KKUMJFAQSA-N Phe-Lys-Ser Chemical compound [H]N[C@@H](CC1=CC=CC=C1)C(=O)N[C@@H](CCCCN)C(=O)N[C@@H](CO)C(O)=O SCKXGHWQPPURGT-KKUMJFAQSA-N 0.000 description 3
- QARPMYDMYVLFMW-KKUMJFAQSA-N Phe-Pro-Glu Chemical compound C([C@H](N)C(=O)N1[C@@H](CCC1)C(=O)N[C@@H](CCC(O)=O)C(O)=O)C1=CC=CC=C1 QARPMYDMYVLFMW-KKUMJFAQSA-N 0.000 description 3
- NJJBATPLUQHRBM-IHRRRGAJSA-N Phe-Pro-Ser Chemical compound C1C[C@H](N(C1)C(=O)[C@H](CC2=CC=CC=C2)N)C(=O)N[C@@H](CO)C(=O)O NJJBATPLUQHRBM-IHRRRGAJSA-N 0.000 description 3
- ZUZINZIJHJFJRN-UBHSHLNASA-N Pro-Phe-Ala Chemical compound C([C@@H](C(=O)N[C@@H](C)C(O)=O)NC(=O)[C@H]1NCCC1)C1=CC=CC=C1 ZUZINZIJHJFJRN-UBHSHLNASA-N 0.000 description 3
- JXVXYRZQIUPYSA-NHCYSSNCSA-N Pro-Val-Gln Chemical compound [H]N1CCC[C@H]1C(=O)N[C@@H](C(C)C)C(=O)N[C@@H](CCC(N)=O)C(O)=O JXVXYRZQIUPYSA-NHCYSSNCSA-N 0.000 description 3
- SQBLRDDJTUJDMV-ACZMJKKPSA-N Ser-Glu-Asn Chemical compound [H]N[C@@H](CO)C(=O)N[C@@H](CCC(O)=O)C(=O)N[C@@H](CC(N)=O)C(O)=O SQBLRDDJTUJDMV-ACZMJKKPSA-N 0.000 description 3
- MFQMZDPAZRZAPV-NAKRPEOUSA-N Ser-Val-Ile Chemical compound CC[C@H](C)[C@@H](C(=O)O)NC(=O)[C@H](C(C)C)NC(=O)[C@H](CO)N MFQMZDPAZRZAPV-NAKRPEOUSA-N 0.000 description 3
- FKIGTIXHSRNKJU-IXOXFDKPSA-N Thr-His-Lys Chemical compound NCCCC[C@@H](C(O)=O)NC(=O)[C@@H](NC(=O)[C@@H](N)[C@H](O)C)CC1=CN=CN1 FKIGTIXHSRNKJU-IXOXFDKPSA-N 0.000 description 3
- XYFISNXATOERFZ-OSUNSFLBSA-N Thr-Ile-Val Chemical compound CC[C@H](C)[C@@H](C(=O)N[C@@H](C(C)C)C(=O)O)NC(=O)[C@H]([C@@H](C)O)N XYFISNXATOERFZ-OSUNSFLBSA-N 0.000 description 3
- JLNMFGCJODTXDH-WEDXCCLWSA-N Thr-Lys-Gly Chemical compound [H]N[C@@H]([C@@H](C)O)C(=O)N[C@@H](CCCCN)C(=O)NCC(O)=O JLNMFGCJODTXDH-WEDXCCLWSA-N 0.000 description 3
- BCYUHPXBHCUYBA-CUJWVEQBSA-N Thr-Ser-His Chemical compound C[C@@H](O)[C@H](N)C(=O)N[C@@H](CO)C(=O)N[C@@H](Cc1cnc[nH]1)C(O)=O BCYUHPXBHCUYBA-CUJWVEQBSA-N 0.000 description 3
- KZTLZZQTJMCGIP-ZJDVBMNYSA-N Thr-Val-Thr Chemical compound [H]N[C@@H]([C@@H](C)O)C(=O)N[C@@H](C(C)C)C(=O)N[C@@H]([C@@H](C)O)C(O)=O KZTLZZQTJMCGIP-ZJDVBMNYSA-N 0.000 description 3
- DVAAUUVLDFKTAQ-VHWLVUOQSA-N Trp-Asp-Ile Chemical compound CC[C@H](C)[C@@H](C(=O)O)NC(=O)[C@H](CC(=O)O)NC(=O)[C@H](CC1=CNC2=CC=CC=C21)N DVAAUUVLDFKTAQ-VHWLVUOQSA-N 0.000 description 3
- PKUJMYZNJMRHEZ-XIRDDKMYSA-N Trp-Glu-Arg Chemical compound [H]N[C@@H](CC1=CNC2=C1C=CC=C2)C(=O)N[C@@H](CCC(O)=O)C(=O)N[C@@H](CCCNC(N)=N)C(O)=O PKUJMYZNJMRHEZ-XIRDDKMYSA-N 0.000 description 3
- CDKZJGMPZHPAJC-ULQDDVLXSA-N Tyr-Leu-Val Chemical compound CC(C)[C@@H](C(O)=O)NC(=O)[C@H](CC(C)C)NC(=O)[C@@H](N)CC1=CC=C(O)C=C1 CDKZJGMPZHPAJC-ULQDDVLXSA-N 0.000 description 3
- AUZADXNWQMBZOO-JYJNAYRXSA-N Tyr-Pro-Arg Chemical compound C([C@H](N)C(=O)N1[C@@H](CCC1)C(=O)N[C@@H](CCCN=C(N)N)C(O)=O)C1=CC=C(O)C=C1 AUZADXNWQMBZOO-JYJNAYRXSA-N 0.000 description 3
- UUJHRSTVQCFDPA-UFYCRDLUSA-N Tyr-Tyr-Val Chemical compound C([C@@H](C(=O)N[C@@H](C(C)C)C(O)=O)NC(=O)[C@@H](N)CC=1C=CC(O)=CC=1)C1=CC=C(O)C=C1 UUJHRSTVQCFDPA-UFYCRDLUSA-N 0.000 description 3
- APQIVBCUIUDSMB-OSUNSFLBSA-N Val-Ile-Thr Chemical compound CC[C@H](C)[C@@H](C(=O)N[C@@H]([C@@H](C)O)C(=O)O)NC(=O)[C@H](C(C)C)N APQIVBCUIUDSMB-OSUNSFLBSA-N 0.000 description 3
- HPANGHISDXDUQY-ULQDDVLXSA-N Val-Lys-Phe Chemical compound CC(C)[C@@H](C(=O)N[C@@H](CCCCN)C(=O)N[C@@H](CC1=CC=CC=C1)C(=O)O)N HPANGHISDXDUQY-ULQDDVLXSA-N 0.000 description 3
- OFQGGTGZTOTLGH-NHCYSSNCSA-N Val-Met-Gln Chemical compound CC(C)[C@@H](C(=O)N[C@@H](CCSC)C(=O)N[C@@H](CCC(=O)N)C(=O)O)N OFQGGTGZTOTLGH-NHCYSSNCSA-N 0.000 description 3
- ZNGPROMGGGFOAA-JYJNAYRXSA-N Val-Tyr-Val Chemical compound CC(C)[C@H](N)C(=O)N[C@H](C(=O)N[C@@H](C(C)C)C(O)=O)CC1=CC=C(O)C=C1 ZNGPROMGGGFOAA-JYJNAYRXSA-N 0.000 description 3
- 241000700647 Variola virus Species 0.000 description 3
- 230000000903 blocking effect Effects 0.000 description 3
- 108020001507 fusion proteins Proteins 0.000 description 3
- 102000037865 fusion proteins Human genes 0.000 description 3
- XBGGUPMXALFZOT-UHFFFAOYSA-N glycyl-L-tyrosine hemihydrate Natural products NCC(=O)NC(C(O)=O)CC1=CC=C(O)C=C1 XBGGUPMXALFZOT-UHFFFAOYSA-N 0.000 description 3
- 108010087823 glycyltyrosine Proteins 0.000 description 3
- 230000002779 inactivation Effects 0.000 description 3
- 230000002601 intratumoral effect Effects 0.000 description 3
- 108010057821 leucylproline Proteins 0.000 description 3
- 108010054155 lysyllysine Proteins 0.000 description 3
- 239000003550 marker Substances 0.000 description 3
- 239000002609 medium Substances 0.000 description 3
- 230000001394 metastastic effect Effects 0.000 description 3
- 206010061289 metastatic neoplasm Diseases 0.000 description 3
- 108010016686 methionyl-alanyl-serine Proteins 0.000 description 3
- 210000000822 natural killer cell Anatomy 0.000 description 3
- 150000003833 nucleoside derivatives Chemical class 0.000 description 3
- 239000000546 pharmaceutical excipient Substances 0.000 description 3
- 108010012581 phenylalanylglutamate Proteins 0.000 description 3
- 108010053725 prolylvaline Proteins 0.000 description 3
- 239000000523 sample Substances 0.000 description 3
- 239000000725 suspension Substances 0.000 description 3
- 230000008685 targeting Effects 0.000 description 3
- 238000001890 transfection Methods 0.000 description 3
- 238000007492 two-way ANOVA Methods 0.000 description 3
- 108010071635 tyrosyl-prolyl-arginine Proteins 0.000 description 3
- 229960005486 vaccine Drugs 0.000 description 3
- 230000009385 viral infection Effects 0.000 description 3
- XLYOFNOQVPJJNP-UHFFFAOYSA-N water Substances O XLYOFNOQVPJJNP-UHFFFAOYSA-N 0.000 description 3
- GJLXVWOMRRWCIB-MERZOTPQSA-N (2S)-2-[[(2S)-2-[[(2S)-2-[[(2S)-2-[[(2S)-2-[[(2S)-2-[[(2S)-2-[[(2S)-2-[[(2S)-2-[[(2S)-2-[[(2S)-2-[[(2S)-2-acetamido-5-(diaminomethylideneamino)pentanoyl]amino]-3-(4-hydroxyphenyl)propanoyl]amino]-3-(4-hydroxyphenyl)propanoyl]amino]-5-(diaminomethylideneamino)pentanoyl]amino]-3-(1H-indol-3-yl)propanoyl]amino]-6-aminohexanoyl]amino]-6-aminohexanoyl]amino]-6-aminohexanoyl]amino]-6-aminohexanoyl]amino]-6-aminohexanoyl]amino]-6-aminohexanoyl]amino]-6-aminohexanamide Chemical compound C([C@H](NC(=O)[C@H](CCCN=C(N)N)NC(=O)C)C(=O)N[C@@H](CC=1C=CC(O)=CC=1)C(=O)N[C@@H](CCCN=C(N)N)C(=O)N[C@@H](CC=1C2=CC=CC=C2NC=1)C(=O)N[C@@H](CCCCN)C(=O)N[C@@H](CCCCN)C(=O)N[C@@H](CCCCN)C(=O)N[C@@H](CCCCN)C(=O)N[C@@H](CCCCN)C(=O)N[C@@H](CCCCN)C(=O)N[C@@H](CCCCN)C(N)=O)C1=CC=C(O)C=C1 GJLXVWOMRRWCIB-MERZOTPQSA-N 0.000 description 2
- ZAYHVCMSTBRABG-JXOAFFINSA-N 5-methylcytidine Chemical compound O=C1N=C(N)C(C)=CN1[C@H]1[C@H](O)[C@H](O)[C@@H](CO)O1 ZAYHVCMSTBRABG-JXOAFFINSA-N 0.000 description 2
- 101150023647 A47L gene Proteins 0.000 description 2
- ZXRQJQCXPSMNMR-XIRDDKMYSA-N Asp-Lys-Trp Chemical compound C1=CC=C2C(=C1)C(=CN2)C[C@@H](C(=O)O)NC(=O)[C@H](CCCCN)NC(=O)[C@H](CC(=O)O)N ZXRQJQCXPSMNMR-XIRDDKMYSA-N 0.000 description 2
- FEJCUYOGOBCFOQ-ACZMJKKPSA-N Cys-Asp-Gln Chemical compound C(CC(=O)N)[C@@H](C(=O)O)NC(=O)[C@H](CC(=O)O)NC(=O)[C@H](CS)N FEJCUYOGOBCFOQ-ACZMJKKPSA-N 0.000 description 2
- 102000004190 Enzymes Human genes 0.000 description 2
- 108090000790 Enzymes Proteins 0.000 description 2
- 108010008177 Fd immunoglobulins Proteins 0.000 description 2
- 108700039691 Genetic Promoter Regions Proteins 0.000 description 2
- WLODHVXYKYHLJD-ACZMJKKPSA-N Gln-Asp-Ser Chemical compound C(CC(=O)N)[C@@H](C(=O)N[C@@H](CC(=O)O)C(=O)N[C@@H](CO)C(=O)O)N WLODHVXYKYHLJD-ACZMJKKPSA-N 0.000 description 2
- WQZGKKKJIJFFOK-GASJEMHNSA-N Glucose Natural products OC[C@H]1OC(O)[C@H](O)[C@@H](O)[C@@H]1O WQZGKKKJIJFFOK-GASJEMHNSA-N 0.000 description 2
- NYHBQMYGNKIUIF-UUOKFMHZSA-N Guanosine Chemical compound C1=NC=2C(=O)NC(N)=NC=2N1[C@@H]1O[C@H](CO)[C@@H](O)[C@H]1O NYHBQMYGNKIUIF-UUOKFMHZSA-N 0.000 description 2
- 108020005004 Guide RNA Proteins 0.000 description 2
- 241000282412 Homo Species 0.000 description 2
- 102000017727 Immunoglobulin Variable Region Human genes 0.000 description 2
- 108010067060 Immunoglobulin Variable Region Proteins 0.000 description 2
- 231100000070 MTS assay Toxicity 0.000 description 2
- 238000000719 MTS assay Methods 0.000 description 2
- 239000012270 PD-1 inhibitor Substances 0.000 description 2
- 239000012668 PD-1-inhibitor Substances 0.000 description 2
- 101710089372 Programmed cell death protein 1 Proteins 0.000 description 2
- 108010029485 Protein Isoforms Proteins 0.000 description 2
- 102000001708 Protein Isoforms Human genes 0.000 description 2
- 238000011529 RT qPCR Methods 0.000 description 2
- FAPWRFPIFSIZLT-UHFFFAOYSA-M Sodium chloride Chemical compound [Na+].[Cl-] FAPWRFPIFSIZLT-UHFFFAOYSA-M 0.000 description 2
- 238000011053 TCID50 method Methods 0.000 description 2
- RVMNUBQWPVOUKH-HEIBUPTGSA-N Thr-Ser-Thr Chemical compound [H]N[C@@H]([C@@H](C)O)C(=O)N[C@@H](CO)C(=O)N[C@@H]([C@@H](C)O)C(O)=O RVMNUBQWPVOUKH-HEIBUPTGSA-N 0.000 description 2
- 108700019146 Transgenes Proteins 0.000 description 2
- DRTQHJPVMGBUCF-XVFCMESISA-N Uridine Chemical compound O[C@@H]1[C@H](O)[C@@H](CO)O[C@H]1N1C(=O)NC(=O)C=C1 DRTQHJPVMGBUCF-XVFCMESISA-N 0.000 description 2
- 208000007097 Urinary Bladder Neoplasms Diseases 0.000 description 2
- 101100161334 Vaccinia virus (strain Western Reserve) VACWR173 gene Proteins 0.000 description 2
- 108700005077 Viral Genes Proteins 0.000 description 2
- 208000036142 Viral infection Diseases 0.000 description 2
- 230000003044 adaptive effect Effects 0.000 description 2
- 101150063416 add gene Proteins 0.000 description 2
- 239000011543 agarose gel Substances 0.000 description 2
- 238000000246 agarose gel electrophoresis Methods 0.000 description 2
- 239000003963 antioxidant agent Substances 0.000 description 2
- 230000005975 antitumor immune response Effects 0.000 description 2
- 230000002238 attenuated effect Effects 0.000 description 2
- 230000008901 benefit Effects 0.000 description 2
- 230000004071 biological effect Effects 0.000 description 2
- 230000008827 biological function Effects 0.000 description 2
- 238000004422 calculation algorithm Methods 0.000 description 2
- 238000004364 calculation method Methods 0.000 description 2
- 238000005119 centrifugation Methods 0.000 description 2
- 238000006243 chemical reaction Methods 0.000 description 2
- 238000002512 chemotherapy Methods 0.000 description 2
- 239000002299 complementary DNA Substances 0.000 description 2
- 150000001875 compounds Chemical class 0.000 description 2
- 231100000433 cytotoxic Toxicity 0.000 description 2
- 230000001472 cytotoxic effect Effects 0.000 description 2
- 230000034994 death Effects 0.000 description 2
- 238000006471 dimerization reaction Methods 0.000 description 2
- 201000010099 disease Diseases 0.000 description 2
- 208000037265 diseases, disorders, signs and symptoms Diseases 0.000 description 2
- 239000012636 effector Substances 0.000 description 2
- 108010030074 endodeoxyribonuclease MluI Proteins 0.000 description 2
- 230000002708 enhancing effect Effects 0.000 description 2
- 230000008029 eradication Effects 0.000 description 2
- 238000011156 evaluation Methods 0.000 description 2
- 238000002474 experimental method Methods 0.000 description 2
- 238000009472 formulation Methods 0.000 description 2
- 230000004927 fusion Effects 0.000 description 2
- 239000008103 glucose Substances 0.000 description 2
- 108010078144 glutaminyl-glycine Proteins 0.000 description 2
- 235000011187 glycerol Nutrition 0.000 description 2
- 230000012010 growth Effects 0.000 description 2
- 230000036541 health Effects 0.000 description 2
- 230000005746 immune checkpoint blockade Effects 0.000 description 2
- 230000028993 immune response Effects 0.000 description 2
- 238000009169 immunotherapy Methods 0.000 description 2
- 238000002513 implantation Methods 0.000 description 2
- 230000003834 intracellular effect Effects 0.000 description 2
- 238000007918 intramuscular administration Methods 0.000 description 2
- 239000003446 ligand Substances 0.000 description 2
- 210000004698 lymphocyte Anatomy 0.000 description 2
- 239000000463 material Substances 0.000 description 2
- 125000003835 nucleoside group Chemical group 0.000 description 2
- 238000001543 one-way ANOVA Methods 0.000 description 2
- 210000000496 pancreas Anatomy 0.000 description 2
- 239000002245 particle Substances 0.000 description 2
- 229940121655 pd-1 inhibitor Drugs 0.000 description 2
- 150000004713 phosphodiesters Chemical class 0.000 description 2
- 108091033319 polynucleotide Proteins 0.000 description 2
- 102000040430 polynucleotide Human genes 0.000 description 2
- 239000002157 polynucleotide Substances 0.000 description 2
- 238000010149 post-hoc-test Methods 0.000 description 2
- 230000000069 prophylactic effect Effects 0.000 description 2
- 238000011002 quantification Methods 0.000 description 2
- 238000001959 radiotherapy Methods 0.000 description 2
- 102000005962 receptors Human genes 0.000 description 2
- 108020003175 receptors Proteins 0.000 description 2
- 230000009467 reduction Effects 0.000 description 2
- 230000003362 replicative effect Effects 0.000 description 2
- 238000011160 research Methods 0.000 description 2
- 150000003839 salts Chemical class 0.000 description 2
- 239000002904 solvent Substances 0.000 description 2
- 238000007619 statistical method Methods 0.000 description 2
- 101150080882 stc gene Proteins 0.000 description 2
- 235000000346 sugar Nutrition 0.000 description 2
- 238000001356 surgical procedure Methods 0.000 description 2
- 230000002103 transcriptional effect Effects 0.000 description 2
- 230000009466 transformation Effects 0.000 description 2
- 230000001052 transient effect Effects 0.000 description 2
- 238000012762 unpaired Student’s t-test Methods 0.000 description 2
- 230000029812 viral genome replication Effects 0.000 description 2
- RIFDKYBNWNPCQK-IOSLPCCCSA-N (2r,3s,4r,5r)-2-(hydroxymethyl)-5-(6-imino-3-methylpurin-9-yl)oxolane-3,4-diol Chemical compound C1=2N(C)C=NC(=N)C=2N=CN1[C@@H]1O[C@H](CO)[C@@H](O)[C@H]1O RIFDKYBNWNPCQK-IOSLPCCCSA-N 0.000 description 1
- XVZCXCTYGHPNEM-IHRRRGAJSA-N (2s)-1-[(2s)-2-[[(2s)-2-amino-4-methylpentanoyl]amino]-4-methylpentanoyl]pyrrolidine-2-carboxylic acid Chemical compound CC(C)C[C@H](N)C(=O)N[C@@H](CC(C)C)C(=O)N1CCC[C@H]1C(O)=O XVZCXCTYGHPNEM-IHRRRGAJSA-N 0.000 description 1
- 102000040650 (ribonucleotides)n+m Human genes 0.000 description 1
- RKSLVDIXBGWPIS-UAKXSSHOSA-N 1-[(2r,3r,4s,5r)-3,4-dihydroxy-5-(hydroxymethyl)oxolan-2-yl]-5-iodopyrimidine-2,4-dione Chemical compound O[C@@H]1[C@H](O)[C@@H](CO)O[C@H]1N1C(=O)NC(=O)C(I)=C1 RKSLVDIXBGWPIS-UAKXSSHOSA-N 0.000 description 1
- QLOCVMVCRJOTTM-TURQNECASA-N 1-[(2r,3r,4s,5r)-3,4-dihydroxy-5-(hydroxymethyl)oxolan-2-yl]-5-prop-1-ynylpyrimidine-2,4-dione Chemical compound O=C1NC(=O)C(C#CC)=CN1[C@H]1[C@H](O)[C@H](O)[C@@H](CO)O1 QLOCVMVCRJOTTM-TURQNECASA-N 0.000 description 1
- PISWNSOQFZRVJK-XLPZGREQSA-N 1-[(2r,4s,5r)-4-hydroxy-5-(hydroxymethyl)oxolan-2-yl]-5-methyl-2-sulfanylidenepyrimidin-4-one Chemical compound S=C1NC(=O)C(C)=CN1[C@@H]1O[C@H](CO)[C@@H](O)C1 PISWNSOQFZRVJK-XLPZGREQSA-N 0.000 description 1
- UHDGCWIWMRVCDJ-UHFFFAOYSA-N 1-beta-D-Xylofuranosyl-NH-Cytosine Natural products O=C1N=C(N)C=CN1C1C(O)C(O)C(CO)O1 UHDGCWIWMRVCDJ-UHFFFAOYSA-N 0.000 description 1
- YKBGVTZYEHREMT-KVQBGUIXSA-N 2'-deoxyguanosine Chemical compound C1=NC=2C(=O)NC(N)=NC=2N1[C@H]1C[C@H](O)[C@@H](CO)O1 YKBGVTZYEHREMT-KVQBGUIXSA-N 0.000 description 1
- CKTSBUTUHBMZGZ-SHYZEUOFSA-N 2'‐deoxycytidine Chemical compound O=C1N=C(N)C=CN1[C@@H]1O[C@H](CO)[C@@H](O)C1 CKTSBUTUHBMZGZ-SHYZEUOFSA-N 0.000 description 1
- JRYMOPZHXMVHTA-DAGMQNCNSA-N 2-amino-7-[(2r,3r,4s,5r)-3,4-dihydroxy-5-(hydroxymethyl)oxolan-2-yl]-1h-pyrrolo[2,3-d]pyrimidin-4-one Chemical compound C1=CC=2C(=O)NC(N)=NC=2N1[C@@H]1O[C@H](CO)[C@@H](O)[C@H]1O JRYMOPZHXMVHTA-DAGMQNCNSA-N 0.000 description 1
- RHFUOMFWUGWKKO-XVFCMESISA-N 2-thiocytidine Chemical compound S=C1N=C(N)C=CN1[C@H]1[C@H](O)[C@H](O)[C@@H](CO)O1 RHFUOMFWUGWKKO-XVFCMESISA-N 0.000 description 1
- LMMLLWZHCKCFQA-UGKPPGOTSA-N 4-amino-1-[(2r,3r,4s,5r)-3,4-dihydroxy-5-(hydroxymethyl)-2-prop-1-ynyloxolan-2-yl]pyrimidin-2-one Chemical compound C1=CC(N)=NC(=O)N1[C@]1(C#CC)O[C@H](CO)[C@@H](O)[C@H]1O LMMLLWZHCKCFQA-UGKPPGOTSA-N 0.000 description 1
- XXSIICQLPUAUDF-TURQNECASA-N 4-amino-1-[(2r,3r,4s,5r)-3,4-dihydroxy-5-(hydroxymethyl)oxolan-2-yl]-5-prop-1-ynylpyrimidin-2-one Chemical compound O=C1N=C(N)C(C#CC)=CN1[C@H]1[C@H](O)[C@H](O)[C@@H](CO)O1 XXSIICQLPUAUDF-TURQNECASA-N 0.000 description 1
- ZAYHVCMSTBRABG-UHFFFAOYSA-N 5-Methylcytidine Natural products O=C1N=C(N)C(C)=CN1C1C(O)C(O)C(CO)O1 ZAYHVCMSTBRABG-UHFFFAOYSA-N 0.000 description 1
- AGFIRQJZCNVMCW-UAKXSSHOSA-N 5-bromouridine Chemical compound O[C@@H]1[C@H](O)[C@@H](CO)O[C@H]1N1C(=O)NC(=O)C(Br)=C1 AGFIRQJZCNVMCW-UAKXSSHOSA-N 0.000 description 1
- FHIDNBAQOFJWCA-UAKXSSHOSA-N 5-fluorouridine Chemical compound O[C@@H]1[C@H](O)[C@@H](CO)O[C@H]1N1C(=O)NC(=O)C(F)=C1 FHIDNBAQOFJWCA-UAKXSSHOSA-N 0.000 description 1
- KDOPAZIWBAHVJB-UHFFFAOYSA-N 5h-pyrrolo[3,2-d]pyrimidine Chemical compound C1=NC=C2NC=CC2=N1 KDOPAZIWBAHVJB-UHFFFAOYSA-N 0.000 description 1
- BXJHWYVXLGLDMZ-UHFFFAOYSA-N 6-O-methylguanine Chemical compound COC1=NC(N)=NC2=C1NC=N2 BXJHWYVXLGLDMZ-UHFFFAOYSA-N 0.000 description 1
- UEHOMUNTZPIBIL-UUOKFMHZSA-N 6-amino-9-[(2r,3r,4s,5r)-3,4-dihydroxy-5-(hydroxymethyl)oxolan-2-yl]-7h-purin-8-one Chemical compound O=C1NC=2C(N)=NC=NC=2N1[C@@H]1O[C@H](CO)[C@@H](O)[C@H]1O UEHOMUNTZPIBIL-UUOKFMHZSA-N 0.000 description 1
- HCAJQHYUCKICQH-VPENINKCSA-N 8-Oxo-7,8-dihydro-2'-deoxyguanosine Chemical compound C1=2NC(N)=NC(=O)C=2NC(=O)N1[C@H]1C[C@H](O)[C@@H](CO)O1 HCAJQHYUCKICQH-VPENINKCSA-N 0.000 description 1
- HDZZVAMISRMYHH-UHFFFAOYSA-N 9beta-Ribofuranosyl-7-deazaadenin Natural products C1=CC=2C(N)=NC=NC=2N1C1OC(CO)C(O)C1O HDZZVAMISRMYHH-UHFFFAOYSA-N 0.000 description 1
- MEFILNJXAVSUTO-JXUBOQSCSA-N Ala-Leu-Thr Chemical compound C[C@H](N)C(=O)N[C@@H](CC(C)C)C(=O)N[C@@H]([C@@H](C)O)C(O)=O MEFILNJXAVSUTO-JXUBOQSCSA-N 0.000 description 1
- PMQXMXAASGFUDX-SRVKXCTJSA-N Ala-Lys-Leu Chemical compound CC(C)C[C@@H](C(O)=O)NC(=O)[C@@H](NC(=O)[C@H](C)N)CCCCN PMQXMXAASGFUDX-SRVKXCTJSA-N 0.000 description 1
- 208000031873 Animal Disease Models Diseases 0.000 description 1
- SLKLLQWZQHXYSV-CIUDSAMLSA-N Asn-Ala-Lys Chemical compound NC(=O)C[C@H](N)C(=O)N[C@@H](C)C(=O)N[C@@H](CCCCN)C(O)=O SLKLLQWZQHXYSV-CIUDSAMLSA-N 0.000 description 1
- QEYJFBMTSMLPKZ-ZKWXMUAHSA-N Asn-Ala-Val Chemical compound [H]N[C@@H](CC(N)=O)C(=O)N[C@@H](C)C(=O)N[C@@H](C(C)C)C(O)=O QEYJFBMTSMLPKZ-ZKWXMUAHSA-N 0.000 description 1
- QISZHYWZHJRDAO-CIUDSAMLSA-N Asn-Asp-Lys Chemical compound C(CCN)C[C@@H](C(=O)O)NC(=O)[C@H](CC(=O)O)NC(=O)[C@H](CC(=O)N)N QISZHYWZHJRDAO-CIUDSAMLSA-N 0.000 description 1
- OLGCWMNDJTWQAG-GUBZILKMSA-N Asn-Glu-Lys Chemical compound NCCCC[C@@H](C(O)=O)NC(=O)[C@H](CCC(O)=O)NC(=O)[C@@H](N)CC(N)=O OLGCWMNDJTWQAG-GUBZILKMSA-N 0.000 description 1
- OSZBYGVKAFZWKC-FXQIFTODSA-N Asn-Pro-Cys Chemical compound NC(=O)C[C@H](N)C(=O)N1CCC[C@H]1C(=O)N[C@@H](CS)C(O)=O OSZBYGVKAFZWKC-FXQIFTODSA-N 0.000 description 1
- FANQWNCPNFEPGZ-WHFBIAKZSA-N Asp-Asp-Gly Chemical compound [H]N[C@@H](CC(O)=O)C(=O)N[C@@H](CC(O)=O)C(=O)NCC(O)=O FANQWNCPNFEPGZ-WHFBIAKZSA-N 0.000 description 1
- DINOVZWPTMGSRF-QXEWZRGKSA-N Asp-Pro-Val Chemical compound [H]N[C@@H](CC(O)=O)C(=O)N1CCC[C@H]1C(=O)N[C@@H](C(C)C)C(O)=O DINOVZWPTMGSRF-QXEWZRGKSA-N 0.000 description 1
- DWRXFEITVBNRMK-UHFFFAOYSA-N Beta-D-1-Arabinofuranosylthymine Natural products O=C1NC(=O)C(C)=CN1C1C(O)C(O)C(CO)O1 DWRXFEITVBNRMK-UHFFFAOYSA-N 0.000 description 1
- 206010005003 Bladder cancer Diseases 0.000 description 1
- 241000283690 Bos taurus Species 0.000 description 1
- 208000003174 Brain Neoplasms Diseases 0.000 description 1
- 206010006187 Breast cancer Diseases 0.000 description 1
- 208000026310 Breast neoplasm Diseases 0.000 description 1
- 239000002126 C01EB10 - Adenosine Substances 0.000 description 1
- 101100462537 Caenorhabditis elegans pac-1 gene Proteins 0.000 description 1
- 241000282472 Canis lupus familiaris Species 0.000 description 1
- 241000283707 Capra Species 0.000 description 1
- 241000282693 Cercopithecidae Species 0.000 description 1
- 241000282994 Cervidae Species 0.000 description 1
- 241000282552 Chlorocebus aethiops Species 0.000 description 1
- 208000005443 Circulating Neoplastic Cells Diseases 0.000 description 1
- 208000001333 Colorectal Neoplasms Diseases 0.000 description 1
- MIKUYHXYGGJMLM-GIMIYPNGSA-N Crotonoside Natural products C1=NC2=C(N)NC(=O)N=C2N1[C@H]1O[C@@H](CO)[C@H](O)[C@@H]1O MIKUYHXYGGJMLM-GIMIYPNGSA-N 0.000 description 1
- BDWIZLQVVWQMTB-XKBZYTNZSA-N Cys-Glu-Thr Chemical compound C[C@H]([C@@H](C(=O)O)NC(=O)[C@H](CCC(=O)O)NC(=O)[C@H](CS)N)O BDWIZLQVVWQMTB-XKBZYTNZSA-N 0.000 description 1
- UHDGCWIWMRVCDJ-PSQAKQOGSA-N Cytidine Natural products O=C1N=C(N)C=CN1[C@@H]1[C@@H](O)[C@@H](O)[C@H](CO)O1 UHDGCWIWMRVCDJ-PSQAKQOGSA-N 0.000 description 1
- 150000008574 D-amino acids Chemical class 0.000 description 1
- NYHBQMYGNKIUIF-UHFFFAOYSA-N D-guanosine Natural products C1=2NC(N)=NC(=O)C=2N=CN1C1OC(CO)C(O)C1O NYHBQMYGNKIUIF-UHFFFAOYSA-N 0.000 description 1
- HMFHBZSHGGEWLO-SOOFDHNKSA-N D-ribofuranose Chemical compound OC[C@H]1OC(O)[C@H](O)[C@@H]1O HMFHBZSHGGEWLO-SOOFDHNKSA-N 0.000 description 1
- 238000007400 DNA extraction Methods 0.000 description 1
- CKTSBUTUHBMZGZ-UHFFFAOYSA-N Deoxycytidine Natural products O=C1N=C(N)C=CN1C1OC(CO)C(O)C1 CKTSBUTUHBMZGZ-UHFFFAOYSA-N 0.000 description 1
- 208000001976 Endocrine Gland Neoplasms Diseases 0.000 description 1
- 208000000461 Esophageal Neoplasms Diseases 0.000 description 1
- 108091092566 Extrachromosomal DNA Proteins 0.000 description 1
- 101150073066 F13L gene Proteins 0.000 description 1
- 108010046276 FLP recombinase Proteins 0.000 description 1
- 241000282326 Felis catus Species 0.000 description 1
- 108090000331 Firefly luciferases Proteins 0.000 description 1
- 101710113436 GTPase KRas Proteins 0.000 description 1
- 241000287828 Gallus gallus Species 0.000 description 1
- 206010017993 Gastrointestinal neoplasms Diseases 0.000 description 1
- QKWBEMCLYTYBNI-GVXVVHGQSA-N Gln-Lys-Val Chemical compound CC(C)[C@@H](C(O)=O)NC(=O)[C@H](CCCCN)NC(=O)[C@@H](N)CCC(N)=O QKWBEMCLYTYBNI-GVXVVHGQSA-N 0.000 description 1
- VCUNGPMMPNJSGS-JYJNAYRXSA-N Gln-Tyr-Lys Chemical compound C1=CC(=CC=C1C[C@@H](C(=O)N[C@@H](CCCCN)C(=O)O)NC(=O)[C@H](CCC(=O)N)N)O VCUNGPMMPNJSGS-JYJNAYRXSA-N 0.000 description 1
- FYBSCGZLICNOBA-XQXXSGGOSA-N Glu-Ala-Thr Chemical compound [H]N[C@@H](CCC(O)=O)C(=O)N[C@@H](C)C(=O)N[C@@H]([C@@H](C)O)C(O)=O FYBSCGZLICNOBA-XQXXSGGOSA-N 0.000 description 1
- VGUYMZGLJUJRBV-YVNDNENWSA-N Glu-Ile-Glu Chemical compound [H]N[C@@H](CCC(O)=O)C(=O)N[C@@H]([C@@H](C)CC)C(=O)N[C@@H](CCC(O)=O)C(O)=O VGUYMZGLJUJRBV-YVNDNENWSA-N 0.000 description 1
- BDISFWMLMNBTGP-NUMRIWBASA-N Glu-Thr-Asp Chemical compound [H]N[C@@H](CCC(O)=O)C(=O)N[C@@H]([C@@H](C)O)C(=O)N[C@@H](CC(O)=O)C(O)=O BDISFWMLMNBTGP-NUMRIWBASA-N 0.000 description 1
- MXJYXYDREQWUMS-XKBZYTNZSA-N Glu-Thr-Ser Chemical compound [H]N[C@@H](CCC(O)=O)C(=O)N[C@@H]([C@@H](C)O)C(=O)N[C@@H](CO)C(O)=O MXJYXYDREQWUMS-XKBZYTNZSA-N 0.000 description 1
- KBBFOULZCHWGJX-KBPBESRZSA-N Gly-Tyr-His Chemical compound C1=CC(=CC=C1C[C@@H](C(=O)N[C@@H](CC2=CN=CN2)C(=O)O)NC(=O)CN)O KBBFOULZCHWGJX-KBPBESRZSA-N 0.000 description 1
- 241000282575 Gorilla Species 0.000 description 1
- 108010043121 Green Fluorescent Proteins Proteins 0.000 description 1
- 102000004144 Green Fluorescent Proteins Human genes 0.000 description 1
- 206010019695 Hepatic neoplasm Diseases 0.000 description 1
- 206010021143 Hypoxia Diseases 0.000 description 1
- BBQABUDWDUKJMB-LZXPERKUSA-N Ile-Ile-Ile Chemical compound CC[C@H](C)[C@H]([NH3+])C(=O)N[C@@H]([C@@H](C)CC)C(=O)N[C@@H]([C@@H](C)CC)C([O-])=O BBQABUDWDUKJMB-LZXPERKUSA-N 0.000 description 1
- FJWALBCCVIHZBS-QXEWZRGKSA-N Ile-Met-Gly Chemical compound CC[C@H](C)[C@@H](C(=O)N[C@@H](CCSC)C(=O)NCC(=O)O)N FJWALBCCVIHZBS-QXEWZRGKSA-N 0.000 description 1
- XLXPYSDGMXTTNQ-DKIMLUQUSA-N Ile-Phe-Leu Chemical compound CC[C@H](C)[C@H](N)C(=O)N[C@@H](Cc1ccccc1)C(=O)N[C@@H](CC(C)C)C(O)=O XLXPYSDGMXTTNQ-DKIMLUQUSA-N 0.000 description 1
- XLXPYSDGMXTTNQ-UHFFFAOYSA-N Ile-Phe-Leu Natural products CCC(C)C(N)C(=O)NC(C(=O)NC(CC(C)C)C(O)=O)CC1=CC=CC=C1 XLXPYSDGMXTTNQ-UHFFFAOYSA-N 0.000 description 1
- UGQMRVRMYYASKQ-KQYNXXCUSA-N Inosine Chemical compound O[C@@H]1[C@H](O)[C@@H](CO)O[C@H]1N1C2=NC=NC(O)=C2N=C1 UGQMRVRMYYASKQ-KQYNXXCUSA-N 0.000 description 1
- 229930010555 Inosine Natural products 0.000 description 1
- 102100030698 Interleukin-12 subunit alpha Human genes 0.000 description 1
- 101710194995 Interleukin-12 subunit alpha Proteins 0.000 description 1
- 102100036701 Interleukin-12 subunit beta Human genes 0.000 description 1
- 101710187487 Interleukin-12 subunit beta Proteins 0.000 description 1
- 102000004556 Interleukin-15 Receptors Human genes 0.000 description 1
- 108010017535 Interleukin-15 Receptors Proteins 0.000 description 1
- 102000015696 Interleukins Human genes 0.000 description 1
- 108010063738 Interleukins Proteins 0.000 description 1
- 108091092195 Intron Proteins 0.000 description 1
- PWWVAXIEGOYWEE-UHFFFAOYSA-N Isophenergan Chemical compound C1=CC=C2N(CC(C)N(C)C)C3=CC=CC=C3SC2=C1 PWWVAXIEGOYWEE-UHFFFAOYSA-N 0.000 description 1
- 101100490479 Lactococcus lactis subsp. lactis (strain IL1403) addA gene Proteins 0.000 description 1
- 101100000975 Lactococcus lactis subsp. lactis (strain IL1403) rexB gene Proteins 0.000 description 1
- 101710119283 Late transcription factor 1 Proteins 0.000 description 1
- 241000880493 Leptailurus serval Species 0.000 description 1
- HRTRLSRYZZKPCO-BJDJZHNGSA-N Leu-Ile-Ser Chemical compound [H]N[C@@H](CC(C)C)C(=O)N[C@@H]([C@@H](C)CC)C(=O)N[C@@H](CO)C(O)=O HRTRLSRYZZKPCO-BJDJZHNGSA-N 0.000 description 1
- AMSSKPUHBUQBOQ-SRVKXCTJSA-N Leu-Ser-Lys Chemical compound CC(C)C[C@@H](C(=O)N[C@@H](CO)C(=O)N[C@@H](CCCCN)C(=O)O)N AMSSKPUHBUQBOQ-SRVKXCTJSA-N 0.000 description 1
- 208000006552 Lewis Lung Carcinoma Diseases 0.000 description 1
- QQUJSUFWEDZQQY-AVGNSLFASA-N Lys-Gln-Lys Chemical compound NCCCC[C@H](N)C(=O)N[C@@H](CCC(N)=O)C(=O)N[C@H](C(O)=O)CCCCN QQUJSUFWEDZQQY-AVGNSLFASA-N 0.000 description 1
- XYLSGAWRCZECIQ-JYJNAYRXSA-N Lys-Tyr-Glu Chemical compound NCCCC[C@H](N)C(=O)N[C@H](C(=O)N[C@@H](CCC(O)=O)C(O)=O)CC1=CC=C(O)C=C1 XYLSGAWRCZECIQ-JYJNAYRXSA-N 0.000 description 1
- 102000018697 Membrane Proteins Human genes 0.000 description 1
- 108010052285 Membrane Proteins Proteins 0.000 description 1
- FRWZTWWOORIIBA-FXQIFTODSA-N Met-Asn-Asn Chemical compound CSCC[C@@H](C(=O)N[C@@H](CC(=O)N)C(=O)N[C@@H](CC(=O)N)C(=O)O)N FRWZTWWOORIIBA-FXQIFTODSA-N 0.000 description 1
- 102100024193 Mitogen-activated protein kinase 1 Human genes 0.000 description 1
- 241001529936 Murinae Species 0.000 description 1
- 241000699660 Mus musculus Species 0.000 description 1
- 101100117764 Mus musculus Dusp2 gene Proteins 0.000 description 1
- KZNQNBZMBZJQJO-UHFFFAOYSA-N N-glycyl-L-proline Natural products NCC(=O)N1CCCC1C(O)=O KZNQNBZMBZJQJO-UHFFFAOYSA-N 0.000 description 1
- 206010052399 Neuroendocrine tumour Diseases 0.000 description 1
- 206010030155 Oesophageal carcinoma Diseases 0.000 description 1
- 108010038807 Oligopeptides Proteins 0.000 description 1
- 102000015636 Oligopeptides Human genes 0.000 description 1
- 206010033128 Ovarian cancer Diseases 0.000 description 1
- 206010061535 Ovarian neoplasm Diseases 0.000 description 1
- 238000012408 PCR amplification Methods 0.000 description 1
- 241000282579 Pan Species 0.000 description 1
- 241001494479 Pecora Species 0.000 description 1
- 108091093037 Peptide nucleic acid Proteins 0.000 description 1
- HCTXJGRYAACKOB-SRVKXCTJSA-N Phe-Asn-Asp Chemical compound C1=CC=C(C=C1)C[C@@H](C(=O)N[C@@H](CC(=O)N)C(=O)N[C@@H](CC(=O)O)C(=O)O)N HCTXJGRYAACKOB-SRVKXCTJSA-N 0.000 description 1
- YZJKNDCEPDDIDA-BZSNNMDCSA-N Phe-His-Lys Chemical compound C([C@@H](C(=O)N[C@@H](CCCCN)C(O)=O)NC(=O)[C@@H](N)CC=1C=CC=CC=1)C1=CN=CN1 YZJKNDCEPDDIDA-BZSNNMDCSA-N 0.000 description 1
- 241000288906 Primates Species 0.000 description 1
- UVKNEILZSJMKSR-FXQIFTODSA-N Pro-Asn-Ala Chemical compound OC(=O)[C@H](C)NC(=O)[C@H](CC(N)=O)NC(=O)[C@@H]1CCCN1 UVKNEILZSJMKSR-FXQIFTODSA-N 0.000 description 1
- ILMLVTGTUJPQFP-FXQIFTODSA-N Pro-Asp-Asp Chemical compound [H]N1CCC[C@H]1C(=O)N[C@@H](CC(O)=O)C(=O)N[C@@H](CC(O)=O)C(O)=O ILMLVTGTUJPQFP-FXQIFTODSA-N 0.000 description 1
- 102000016611 Proteoglycans Human genes 0.000 description 1
- 108010067787 Proteoglycans Proteins 0.000 description 1
- 102220465562 Putative uncharacterized protein OBSCN-AS1_F13L_mutation Human genes 0.000 description 1
- 241000700159 Rattus Species 0.000 description 1
- 208000015634 Rectal Neoplasms Diseases 0.000 description 1
- 108700008625 Reporter Genes Proteins 0.000 description 1
- PYMYPHUHKUWMLA-LMVFSUKVSA-N Ribose Natural products OC[C@@H](O)[C@@H](O)[C@@H](O)C=O PYMYPHUHKUWMLA-LMVFSUKVSA-N 0.000 description 1
- 241000282849 Ruminantia Species 0.000 description 1
- 206010039491 Sarcoma Diseases 0.000 description 1
- GHPQVUYZQQGEDA-BIIVOSGPSA-N Ser-Asp-Pro Chemical compound C1C[C@@H](N(C1)C(=O)[C@H](CC(=O)O)NC(=O)[C@H](CO)N)C(=O)O GHPQVUYZQQGEDA-BIIVOSGPSA-N 0.000 description 1
- ZIFYDQAFEMIZII-GUBZILKMSA-N Ser-Leu-Glu Chemical compound [H]N[C@@H](CO)C(=O)N[C@@H](CC(C)C)C(=O)N[C@@H](CCC(O)=O)C(O)=O ZIFYDQAFEMIZII-GUBZILKMSA-N 0.000 description 1
- PPNPDKGQRFSCAC-CIUDSAMLSA-N Ser-Lys-Asp Chemical compound NCCCC[C@H](NC(=O)[C@@H](N)CO)C(=O)N[C@@H](CC(O)=O)C(O)=O PPNPDKGQRFSCAC-CIUDSAMLSA-N 0.000 description 1
- XZKQVQKUZMAADP-IMJSIDKUSA-N Ser-Ser Chemical compound OC[C@H](N)C(=O)N[C@@H](CO)C(O)=O XZKQVQKUZMAADP-IMJSIDKUSA-N 0.000 description 1
- PPCZVWHJWJFTFN-ZLUOBGJFSA-N Ser-Ser-Asp Chemical compound [H]N[C@@H](CO)C(=O)N[C@@H](CO)C(=O)N[C@@H](CC(O)=O)C(O)=O PPCZVWHJWJFTFN-ZLUOBGJFSA-N 0.000 description 1
- 108020004682 Single-Stranded DNA Proteins 0.000 description 1
- 208000000453 Skin Neoplasms Diseases 0.000 description 1
- 208000005718 Stomach Neoplasms Diseases 0.000 description 1
- 241000282887 Suidae Species 0.000 description 1
- 210000001744 T-lymphocyte Anatomy 0.000 description 1
- 208000024313 Testicular Neoplasms Diseases 0.000 description 1
- 206010057644 Testis cancer Diseases 0.000 description 1
- UZJDBCHMIQXLOQ-HEIBUPTGSA-N Thr-Cys-Thr Chemical compound C[C@H]([C@@H](C(=O)N[C@@H](CS)C(=O)N[C@@H]([C@@H](C)O)C(=O)O)N)O UZJDBCHMIQXLOQ-HEIBUPTGSA-N 0.000 description 1
- PCMDGXKXVMBIFP-VEVYYDQMSA-N Thr-Met-Asn Chemical compound [H]N[C@@H]([C@@H](C)O)C(=O)N[C@@H](CCSC)C(=O)N[C@@H](CC(N)=O)C(O)=O PCMDGXKXVMBIFP-VEVYYDQMSA-N 0.000 description 1
- MXNAOGFNFNKUPD-JHYOHUSXSA-N Thr-Phe-Thr Chemical compound [H]N[C@@H]([C@@H](C)O)C(=O)N[C@@H](CC1=CC=CC=C1)C(=O)N[C@@H]([C@@H](C)O)C(O)=O MXNAOGFNFNKUPD-JHYOHUSXSA-N 0.000 description 1
- WKGAAMOJPMBBMC-IXOXFDKPSA-N Thr-Ser-Phe Chemical compound [H]N[C@@H]([C@@H](C)O)C(=O)N[C@@H](CO)C(=O)N[C@@H](CC1=CC=CC=C1)C(O)=O WKGAAMOJPMBBMC-IXOXFDKPSA-N 0.000 description 1
- TZQWJCGVCIJDMU-HEIBUPTGSA-N Thr-Thr-Cys Chemical compound C[C@H]([C@@H](C(=O)N[C@@H]([C@@H](C)O)C(=O)N[C@@H](CS)C(=O)O)N)O TZQWJCGVCIJDMU-HEIBUPTGSA-N 0.000 description 1
- ABCLYRRGTZNIFU-BWAGICSOSA-N Thr-Tyr-His Chemical compound C[C@H]([C@@H](C(=O)N[C@@H](CC1=CC=C(C=C1)O)C(=O)N[C@@H](CC2=CN=CN2)C(=O)O)N)O ABCLYRRGTZNIFU-BWAGICSOSA-N 0.000 description 1
- QNXZCKMXHPULME-ZNSHCXBVSA-N Thr-Val-Pro Chemical compound C[C@H]([C@@H](C(=O)N[C@@H](C(C)C)C(=O)N1CCC[C@@H]1C(=O)O)N)O QNXZCKMXHPULME-ZNSHCXBVSA-N 0.000 description 1
- 108091036066 Three prime untranslated region Proteins 0.000 description 1
- 208000037432 Thymic tumor Diseases 0.000 description 1
- 208000000728 Thymus Neoplasms Diseases 0.000 description 1
- 108700025716 Tumor Suppressor Genes Proteins 0.000 description 1
- 102000044209 Tumor Suppressor Genes Human genes 0.000 description 1
- LOOCQRRBKZTPKO-AVGNSLFASA-N Tyr-Glu-Asn Chemical compound NC(=O)C[C@@H](C(O)=O)NC(=O)[C@H](CCC(O)=O)NC(=O)[C@@H](N)CC1=CC=C(O)C=C1 LOOCQRRBKZTPKO-AVGNSLFASA-N 0.000 description 1
- WAPFQMXRSDEGOE-IHRRRGAJSA-N Tyr-Glu-Gln Chemical compound [H]N[C@@H](CC1=CC=C(O)C=C1)C(=O)N[C@@H](CCC(O)=O)C(=O)N[C@@H](CCC(N)=O)C(O)=O WAPFQMXRSDEGOE-IHRRRGAJSA-N 0.000 description 1
- WPXKRJVHBXYLDT-JUKXBJQTSA-N Tyr-His-Ile Chemical compound CC[C@H](C)[C@@H](C(=O)O)NC(=O)[C@H](CC1=CN=CN1)NC(=O)[C@H](CC2=CC=C(C=C2)O)N WPXKRJVHBXYLDT-JUKXBJQTSA-N 0.000 description 1
- JHORGUYURUBVOM-KKUMJFAQSA-N Tyr-His-Ser Chemical compound [H]N[C@@H](CC1=CC=C(O)C=C1)C(=O)N[C@@H](CC1=CNC=N1)C(=O)N[C@@H](CO)C(O)=O JHORGUYURUBVOM-KKUMJFAQSA-N 0.000 description 1
- 208000008385 Urogenital Neoplasms Diseases 0.000 description 1
- 208000002495 Uterine Neoplasms Diseases 0.000 description 1
- 101100502046 Vaccinia virus (strain Western Reserve) VACWR052 gene Proteins 0.000 description 1
- 101900137037 Vaccinia virus Late transcription factor 1 Proteins 0.000 description 1
- DNOOLPROHJWCSQ-RCWTZXSCSA-N Val-Arg-Thr Chemical compound CC(C)[C@H](N)C(=O)N[C@@H](CCCN=C(N)N)C(=O)N[C@@H]([C@@H](C)O)C(O)=O DNOOLPROHJWCSQ-RCWTZXSCSA-N 0.000 description 1
- KOPBYUSPXBQIHD-NRPADANISA-N Val-Cys-Glu Chemical compound CC(C)[C@@H](C(=O)N[C@@H](CS)C(=O)N[C@@H](CCC(=O)O)C(=O)O)N KOPBYUSPXBQIHD-NRPADANISA-N 0.000 description 1
- APEBUJBRGCMMHP-HJWJTTGWSA-N Val-Ile-Phe Chemical compound CC(C)[C@H](N)C(=O)N[C@@H]([C@@H](C)CC)C(=O)N[C@H](C(O)=O)CC1=CC=CC=C1 APEBUJBRGCMMHP-HJWJTTGWSA-N 0.000 description 1
- DJQIUOKSNRBTSV-CYDGBPFRSA-N Val-Ile-Val Chemical compound CC[C@H](C)[C@@H](C(=O)N[C@@H](C(C)C)C(=O)O)NC(=O)[C@H](C(C)C)N DJQIUOKSNRBTSV-CYDGBPFRSA-N 0.000 description 1
- MIKHIIQMRFYVOR-RCWTZXSCSA-N Val-Pro-Thr Chemical compound C[C@H]([C@@H](C(=O)O)NC(=O)[C@@H]1CCCN1C(=O)[C@H](C(C)C)N)O MIKHIIQMRFYVOR-RCWTZXSCSA-N 0.000 description 1
- PDDJTOSAVNRJRH-UNQGMJICSA-N Val-Thr-Phe Chemical compound C[C@H]([C@@H](C(=O)N[C@@H](CC1=CC=CC=C1)C(=O)O)NC(=O)[C@H](C(C)C)N)O PDDJTOSAVNRJRH-UNQGMJICSA-N 0.000 description 1
- VVIZITNVZUAEMI-DLOVCJGASA-N Val-Val-Gln Chemical compound CC(C)[C@H](N)C(=O)N[C@@H](C(C)C)C(=O)N[C@H](C(O)=O)CCC(N)=O VVIZITNVZUAEMI-DLOVCJGASA-N 0.000 description 1
- 101100502047 Variola virus (isolate Human/India/Ind3/1967) C17L gene Proteins 0.000 description 1
- 238000009825 accumulation Methods 0.000 description 1
- 230000021736 acetylation Effects 0.000 description 1
- 238000006640 acetylation reaction Methods 0.000 description 1
- 230000004913 activation Effects 0.000 description 1
- 239000013543 active substance Substances 0.000 description 1
- 210000005006 adaptive immune system Anatomy 0.000 description 1
- 208000009956 adenocarcinoma Diseases 0.000 description 1
- 229960005305 adenosine Drugs 0.000 description 1
- 150000001298 alcohols Chemical class 0.000 description 1
- HMFHBZSHGGEWLO-UHFFFAOYSA-N alpha-D-Furanose-Ribose Natural products OCC1OC(O)C(O)C1O HMFHBZSHGGEWLO-UHFFFAOYSA-N 0.000 description 1
- 230000009435 amidation Effects 0.000 description 1
- 238000007112 amidation reaction Methods 0.000 description 1
- 238000004458 analytical method Methods 0.000 description 1
- 238000011558 animal model by disease Methods 0.000 description 1
- 238000011122 anti-angiogenic therapy Methods 0.000 description 1
- 230000001093 anti-cancer Effects 0.000 description 1
- 230000002137 anti-vascular effect Effects 0.000 description 1
- 238000009175 antibody therapy Methods 0.000 description 1
- 230000030741 antigen processing and presentation Effects 0.000 description 1
- 239000002246 antineoplastic agent Substances 0.000 description 1
- 238000003782 apoptosis assay Methods 0.000 description 1
- PYMYPHUHKUWMLA-WDCZJNDASA-N arabinose Chemical compound OC[C@@H](O)[C@@H](O)[C@H](O)C=O PYMYPHUHKUWMLA-WDCZJNDASA-N 0.000 description 1
- PYMYPHUHKUWMLA-UHFFFAOYSA-N arabinose Natural products OCC(O)C(O)C(O)C=O PYMYPHUHKUWMLA-UHFFFAOYSA-N 0.000 description 1
- 108010077245 asparaginyl-proline Proteins 0.000 description 1
- 229960003852 atezolizumab Drugs 0.000 description 1
- 229950002916 avelumab Drugs 0.000 description 1
- SRBFZHDQGSBBOR-UHFFFAOYSA-N beta-D-Pyranose-Lyxose Natural products OC1COC(O)C(O)C1O SRBFZHDQGSBBOR-UHFFFAOYSA-N 0.000 description 1
- IQFYYKKMVGJFEH-UHFFFAOYSA-N beta-L-thymidine Natural products O=C1NC(=O)C(C)=CN1C1OC(CO)C(O)C1 IQFYYKKMVGJFEH-UHFFFAOYSA-N 0.000 description 1
- DRTQHJPVMGBUCF-PSQAKQOGSA-N beta-L-uridine Natural products O[C@H]1[C@@H](O)[C@H](CO)O[C@@H]1N1C(=O)NC(=O)C=C1 DRTQHJPVMGBUCF-PSQAKQOGSA-N 0.000 description 1
- 230000005540 biological transmission Effects 0.000 description 1
- 238000001815 biotherapy Methods 0.000 description 1
- 239000006172 buffering agent Substances 0.000 description 1
- 230000030833 cell death Effects 0.000 description 1
- 239000013592 cell lysate Substances 0.000 description 1
- 230000006037 cell lysis Effects 0.000 description 1
- 201000007455 central nervous system cancer Diseases 0.000 description 1
- 208000025997 central nervous system neoplasm Diseases 0.000 description 1
- 239000003795 chemical substances by application Substances 0.000 description 1
- 235000013330 chicken meat Nutrition 0.000 description 1
- 239000013611 chromosomal DNA Substances 0.000 description 1
- 238000010367 cloning Methods 0.000 description 1
- 239000011248 coating agent Substances 0.000 description 1
- 230000000112 colonic effect Effects 0.000 description 1
- 239000003086 colorant Substances 0.000 description 1
- 230000000052 comparative effect Effects 0.000 description 1
- 238000011109 contamination Methods 0.000 description 1
- 238000011443 conventional therapy Methods 0.000 description 1
- 238000000315 cryotherapy Methods 0.000 description 1
- 108010082025 cyan fluorescent protein Proteins 0.000 description 1
- UHDGCWIWMRVCDJ-ZAKLUEHWSA-N cytidine Chemical compound O=C1N=C(N)C=CN1[C@H]1[C@H](O)[C@@H](O)[C@H](CO)O1 UHDGCWIWMRVCDJ-ZAKLUEHWSA-N 0.000 description 1
- 239000000824 cytostatic agent Substances 0.000 description 1
- 230000001085 cytostatic effect Effects 0.000 description 1
- 229940127089 cytotoxic agent Drugs 0.000 description 1
- 230000003247 decreasing effect Effects 0.000 description 1
- 230000007123 defense Effects 0.000 description 1
- 230000007812 deficiency Effects 0.000 description 1
- 230000001627 detrimental effect Effects 0.000 description 1
- 231100000673 dose–response relationship Toxicity 0.000 description 1
- 229940079593 drug Drugs 0.000 description 1
- 239000003937 drug carrier Substances 0.000 description 1
- 230000009977 dual effect Effects 0.000 description 1
- 229950009791 durvalumab Drugs 0.000 description 1
- 239000003995 emulsifying agent Substances 0.000 description 1
- 201000011523 endocrine gland cancer Diseases 0.000 description 1
- 102000052116 epidermal growth factor receptor activity proteins Human genes 0.000 description 1
- 108700015053 epidermal growth factor receptor activity proteins Proteins 0.000 description 1
- 201000004101 esophageal cancer Diseases 0.000 description 1
- 230000001747 exhibiting effect Effects 0.000 description 1
- 208000021045 exocrine pancreatic carcinoma Diseases 0.000 description 1
- 239000013604 expression vector Substances 0.000 description 1
- 239000000796 flavoring agent Substances 0.000 description 1
- 108010021843 fluorescent protein 583 Proteins 0.000 description 1
- 235000013355 food flavoring agent Nutrition 0.000 description 1
- 235000003599 food sweetener Nutrition 0.000 description 1
- 206010017758 gastric cancer Diseases 0.000 description 1
- 238000012224 gene deletion Methods 0.000 description 1
- 230000030279 gene silencing Effects 0.000 description 1
- 108091006104 gene-regulatory proteins Proteins 0.000 description 1
- 102000034356 gene-regulatory proteins Human genes 0.000 description 1
- 108010049041 glutamylalanine Proteins 0.000 description 1
- 108010077515 glycylproline Proteins 0.000 description 1
- 239000008187 granular material Substances 0.000 description 1
- 239000005090 green fluorescent protein Substances 0.000 description 1
- 239000003102 growth factor Substances 0.000 description 1
- 229940029575 guanosine Drugs 0.000 description 1
- 201000010536 head and neck cancer Diseases 0.000 description 1
- 208000014829 head and neck neoplasm Diseases 0.000 description 1
- 201000005787 hematologic cancer Diseases 0.000 description 1
- 208000024200 hematopoietic and lymphoid system neoplasm Diseases 0.000 description 1
- 150000002402 hexoses Chemical class 0.000 description 1
- 108010018006 histidylserine Proteins 0.000 description 1
- 238000001794 hormone therapy Methods 0.000 description 1
- 206010020718 hyperplasia Diseases 0.000 description 1
- 230000001146 hypoxic effect Effects 0.000 description 1
- 230000001900 immune effect Effects 0.000 description 1
- 210000000987 immune system Anatomy 0.000 description 1
- 238000002649 immunization Methods 0.000 description 1
- 230000003053 immunization Effects 0.000 description 1
- 230000002163 immunogen Effects 0.000 description 1
- 239000002955 immunomodulating agent Substances 0.000 description 1
- 230000006872 improvement Effects 0.000 description 1
- 230000002401 inhibitory effect Effects 0.000 description 1
- 210000005007 innate immune system Anatomy 0.000 description 1
- 229960003786 inosine Drugs 0.000 description 1
- 230000010354 integration Effects 0.000 description 1
- 238000001361 intraarterial administration Methods 0.000 description 1
- 238000007913 intrathecal administration Methods 0.000 description 1
- 238000011835 investigation Methods 0.000 description 1
- 210000003292 kidney cell Anatomy 0.000 description 1
- 230000002147 killing effect Effects 0.000 description 1
- 101150066555 lacZ gene Proteins 0.000 description 1
- 230000000670 limiting effect Effects 0.000 description 1
- 239000007788 liquid Substances 0.000 description 1
- 208000014018 liver neoplasm Diseases 0.000 description 1
- 230000007774 longterm Effects 0.000 description 1
- 210000004324 lymphatic system Anatomy 0.000 description 1
- 108010038320 lysylphenylalanine Proteins 0.000 description 1
- 230000002101 lytic effect Effects 0.000 description 1
- 239000011159 matrix material Substances 0.000 description 1
- 230000007246 mechanism Effects 0.000 description 1
- 201000001441 melanoma Diseases 0.000 description 1
- 210000004379 membrane Anatomy 0.000 description 1
- 239000012528 membrane Substances 0.000 description 1
- 230000011987 methylation Effects 0.000 description 1
- 238000007069 methylation reaction Methods 0.000 description 1
- 238000002941 microtiter virus yield reduction assay Methods 0.000 description 1
- 238000010369 molecular cloning Methods 0.000 description 1
- YOHYSYJDKVYCJI-UHFFFAOYSA-N n-[3-[[6-[3-(trifluoromethyl)anilino]pyrimidin-4-yl]amino]phenyl]cyclopropanecarboxamide Chemical compound FC(F)(F)C1=CC=CC(NC=2N=CN=C(NC=3C=C(NC(=O)C4CC4)C=CC=3)C=2)=C1 YOHYSYJDKVYCJI-UHFFFAOYSA-N 0.000 description 1
- 208000016065 neuroendocrine neoplasm Diseases 0.000 description 1
- 201000011519 neuroendocrine tumor Diseases 0.000 description 1
- 230000003472 neutralizing effect Effects 0.000 description 1
- 229960003301 nivolumab Drugs 0.000 description 1
- 238000011580 nude mouse model Methods 0.000 description 1
- 108700025694 p53 Genes Proteins 0.000 description 1
- 238000007911 parenteral administration Methods 0.000 description 1
- 230000037361 pathway Effects 0.000 description 1
- 229960002621 pembrolizumab Drugs 0.000 description 1
- GJVFBWCTGUSGDD-UHFFFAOYSA-L pentamethonium bromide Chemical compound [Br-].[Br-].C[N+](C)(C)CCCCC[N+](C)(C)C GJVFBWCTGUSGDD-UHFFFAOYSA-L 0.000 description 1
- 230000002093 peripheral effect Effects 0.000 description 1
- 210000003200 peritoneal cavity Anatomy 0.000 description 1
- 210000004303 peritoneum Anatomy 0.000 description 1
- 230000002688 persistence Effects 0.000 description 1
- 125000002467 phosphate group Chemical group [H]OP(=O)(O[H])O[*] 0.000 description 1
- 229950010773 pidilizumab Drugs 0.000 description 1
- 229920000642 polymer Polymers 0.000 description 1
- 229920005862 polyol Polymers 0.000 description 1
- 150000003077 polyols Chemical class 0.000 description 1
- 230000001124 posttranscriptional effect Effects 0.000 description 1
- 230000003389 potentiating effect Effects 0.000 description 1
- 244000144977 poultry Species 0.000 description 1
- 235000013594 poultry meat Nutrition 0.000 description 1
- 239000000843 powder Substances 0.000 description 1
- 239000003755 preservative agent Substances 0.000 description 1
- 230000002265 prevention Effects 0.000 description 1
- 230000000861 pro-apoptotic effect Effects 0.000 description 1
- 230000008569 process Effects 0.000 description 1
- 230000005522 programmed cell death Effects 0.000 description 1
- 238000001243 protein synthesis Methods 0.000 description 1
- 108010014186 ras Proteins Proteins 0.000 description 1
- 238000003753 real-time PCR Methods 0.000 description 1
- 238000003259 recombinant expression Methods 0.000 description 1
- 206010038038 rectal cancer Diseases 0.000 description 1
- 201000001275 rectum cancer Diseases 0.000 description 1
- 230000000306 recurrent effect Effects 0.000 description 1
- 238000009256 replacement therapy Methods 0.000 description 1
- 238000002271 resection Methods 0.000 description 1
- 230000000241 respiratory effect Effects 0.000 description 1
- RHFUOMFWUGWKKO-UHFFFAOYSA-N s2C Natural products S=C1N=C(N)C=CN1C1C(O)C(O)C(CO)O1 RHFUOMFWUGWKKO-UHFFFAOYSA-N 0.000 description 1
- 238000007790 scraping Methods 0.000 description 1
- 201000000849 skin cancer Diseases 0.000 description 1
- 239000011780 sodium chloride Substances 0.000 description 1
- 206010041823 squamous cell carcinoma Diseases 0.000 description 1
- 239000003381 stabilizer Substances 0.000 description 1
- 201000011549 stomach cancer Diseases 0.000 description 1
- 238000010254 subcutaneous injection Methods 0.000 description 1
- 239000007929 subcutaneous injection Substances 0.000 description 1
- 150000008163 sugars Chemical class 0.000 description 1
- 239000006228 supernatant Substances 0.000 description 1
- 239000000375 suspending agent Substances 0.000 description 1
- 239000003765 sweetening agent Substances 0.000 description 1
- 238000003786 synthesis reaction Methods 0.000 description 1
- 230000009885 systemic effect Effects 0.000 description 1
- 239000003826 tablet Substances 0.000 description 1
- 201000003120 testicular cancer Diseases 0.000 description 1
- 229940124597 therapeutic agent Drugs 0.000 description 1
- 239000002562 thickening agent Substances 0.000 description 1
- RYYWUUFWQRZTIU-UHFFFAOYSA-K thiophosphate Chemical compound [O-]P([O-])([O-])=S RYYWUUFWQRZTIU-UHFFFAOYSA-K 0.000 description 1
- 229940104230 thymidine Drugs 0.000 description 1
- 201000009377 thymus cancer Diseases 0.000 description 1
- 230000000699 topical effect Effects 0.000 description 1
- 231100000331 toxic Toxicity 0.000 description 1
- 230000002588 toxic effect Effects 0.000 description 1
- 239000003053 toxin Substances 0.000 description 1
- 231100000765 toxin Toxicity 0.000 description 1
- 238000013518 transcription Methods 0.000 description 1
- 230000035897 transcription Effects 0.000 description 1
- 238000011830 transgenic mouse model Methods 0.000 description 1
- 230000014616 translation Effects 0.000 description 1
- 238000011269 treatment regimen Methods 0.000 description 1
- HDZZVAMISRMYHH-KCGFPETGSA-N tubercidin Chemical compound C1=CC=2C(N)=NC=NC=2N1[C@@H]1O[C@H](CO)[C@@H](O)[C@H]1O HDZZVAMISRMYHH-KCGFPETGSA-N 0.000 description 1
- 108010051110 tyrosyl-lysine Proteins 0.000 description 1
- 238000005199 ultracentrifugation Methods 0.000 description 1
- DRTQHJPVMGBUCF-UHFFFAOYSA-N uracil arabinoside Natural products OC1C(O)C(CO)OC1N1C(=O)NC(=O)C=C1 DRTQHJPVMGBUCF-UHFFFAOYSA-N 0.000 description 1
- 229940045145 uridine Drugs 0.000 description 1
- 201000005112 urinary bladder cancer Diseases 0.000 description 1
- 206010046766 uterine cancer Diseases 0.000 description 1
- 238000002255 vaccination Methods 0.000 description 1
- 238000010200 validation analysis Methods 0.000 description 1
- 235000015112 vegetable and seed oil Nutrition 0.000 description 1
- 239000008158 vegetable oil Substances 0.000 description 1
- 210000003462 vein Anatomy 0.000 description 1
- 238000012795 verification Methods 0.000 description 1
- 210000002845 virion Anatomy 0.000 description 1
- 230000001018 virulence Effects 0.000 description 1
- 238000011179 visual inspection Methods 0.000 description 1
- 239000008215 water for injection Substances 0.000 description 1
- 239000000080 wetting agent Substances 0.000 description 1
- 108091005957 yellow fluorescent proteins Proteins 0.000 description 1
Images
Classifications
-
- C—CHEMISTRY; METALLURGY
- C12—BIOCHEMISTRY; BEER; SPIRITS; WINE; VINEGAR; MICROBIOLOGY; ENZYMOLOGY; MUTATION OR GENETIC ENGINEERING
- C12N—MICROORGANISMS OR ENZYMES; COMPOSITIONS THEREOF; PROPAGATING, PRESERVING, OR MAINTAINING MICROORGANISMS; MUTATION OR GENETIC ENGINEERING; CULTURE MEDIA
- C12N15/00—Mutation or genetic engineering; DNA or RNA concerning genetic engineering, vectors, e.g. plasmids, or their isolation, preparation or purification; Use of hosts therefor
- C12N15/09—Recombinant DNA-technology
- C12N15/63—Introduction of foreign genetic material using vectors; Vectors; Use of hosts therefor; Regulation of expression
- C12N15/79—Vectors or expression systems specially adapted for eukaryotic hosts
- C12N15/85—Vectors or expression systems specially adapted for eukaryotic hosts for animal cells
- C12N15/86—Viral vectors
-
- A—HUMAN NECESSITIES
- A61—MEDICAL OR VETERINARY SCIENCE; HYGIENE
- A61K—PREPARATIONS FOR MEDICAL, DENTAL OR TOILETRY PURPOSES
- A61K39/00—Medicinal preparations containing antigens or antibodies
- A61K39/12—Viral antigens
- A61K39/275—Poxviridae, e.g. avipoxvirus
- A61K39/285—Vaccinia virus or variola virus
-
- A—HUMAN NECESSITIES
- A61—MEDICAL OR VETERINARY SCIENCE; HYGIENE
- A61K—PREPARATIONS FOR MEDICAL, DENTAL OR TOILETRY PURPOSES
- A61K35/00—Medicinal preparations containing materials or reaction products thereof with undetermined constitution
- A61K35/66—Microorganisms or materials therefrom
- A61K35/76—Viruses; Subviral particles; Bacteriophages
- A61K35/768—Oncolytic viruses not provided for in groups A61K35/761 - A61K35/766
-
- A—HUMAN NECESSITIES
- A61—MEDICAL OR VETERINARY SCIENCE; HYGIENE
- A61K—PREPARATIONS FOR MEDICAL, DENTAL OR TOILETRY PURPOSES
- A61K38/00—Medicinal preparations containing peptides
- A61K38/16—Peptides having more than 20 amino acids; Gastrins; Somatostatins; Melanotropins; Derivatives thereof
- A61K38/17—Peptides having more than 20 amino acids; Gastrins; Somatostatins; Melanotropins; Derivatives thereof from animals; from humans
- A61K38/19—Cytokines; Lymphokines; Interferons
- A61K38/20—Interleukins [IL]
-
- A—HUMAN NECESSITIES
- A61—MEDICAL OR VETERINARY SCIENCE; HYGIENE
- A61K—PREPARATIONS FOR MEDICAL, DENTAL OR TOILETRY PURPOSES
- A61K38/00—Medicinal preparations containing peptides
- A61K38/16—Peptides having more than 20 amino acids; Gastrins; Somatostatins; Melanotropins; Derivatives thereof
- A61K38/17—Peptides having more than 20 amino acids; Gastrins; Somatostatins; Melanotropins; Derivatives thereof from animals; from humans
- A61K38/19—Cytokines; Lymphokines; Interferons
- A61K38/20—Interleukins [IL]
- A61K38/208—IL-12
-
- A—HUMAN NECESSITIES
- A61—MEDICAL OR VETERINARY SCIENCE; HYGIENE
- A61P—SPECIFIC THERAPEUTIC ACTIVITY OF CHEMICAL COMPOUNDS OR MEDICINAL PREPARATIONS
- A61P35/00—Antineoplastic agents
-
- C—CHEMISTRY; METALLURGY
- C07—ORGANIC CHEMISTRY
- C07K—PEPTIDES
- C07K14/00—Peptides having more than 20 amino acids; Gastrins; Somatostatins; Melanotropins; Derivatives thereof
- C07K14/435—Peptides having more than 20 amino acids; Gastrins; Somatostatins; Melanotropins; Derivatives thereof from animals; from humans
- C07K14/52—Cytokines; Lymphokines; Interferons
- C07K14/54—Interleukins [IL]
- C07K14/5434—IL-12
-
- C—CHEMISTRY; METALLURGY
- C07—ORGANIC CHEMISTRY
- C07K—PEPTIDES
- C07K14/00—Peptides having more than 20 amino acids; Gastrins; Somatostatins; Melanotropins; Derivatives thereof
- C07K14/435—Peptides having more than 20 amino acids; Gastrins; Somatostatins; Melanotropins; Derivatives thereof from animals; from humans
- C07K14/705—Receptors; Cell surface antigens; Cell surface determinants
- C07K14/70503—Immunoglobulin superfamily
- C07K14/70521—CD28, CD152
-
- C—CHEMISTRY; METALLURGY
- C07—ORGANIC CHEMISTRY
- C07K—PEPTIDES
- C07K14/00—Peptides having more than 20 amino acids; Gastrins; Somatostatins; Melanotropins; Derivatives thereof
- C07K14/435—Peptides having more than 20 amino acids; Gastrins; Somatostatins; Melanotropins; Derivatives thereof from animals; from humans
- C07K14/705—Receptors; Cell surface antigens; Cell surface determinants
- C07K14/70503—Immunoglobulin superfamily
- C07K14/70532—B7 molecules, e.g. CD80, CD86
-
- C—CHEMISTRY; METALLURGY
- C12—BIOCHEMISTRY; BEER; SPIRITS; WINE; VINEGAR; MICROBIOLOGY; ENZYMOLOGY; MUTATION OR GENETIC ENGINEERING
- C12N—MICROORGANISMS OR ENZYMES; COMPOSITIONS THEREOF; PROPAGATING, PRESERVING, OR MAINTAINING MICROORGANISMS; MUTATION OR GENETIC ENGINEERING; CULTURE MEDIA
- C12N7/00—Viruses; Bacteriophages; Compositions thereof; Preparation or purification thereof
-
- A—HUMAN NECESSITIES
- A61—MEDICAL OR VETERINARY SCIENCE; HYGIENE
- A61K—PREPARATIONS FOR MEDICAL, DENTAL OR TOILETRY PURPOSES
- A61K39/00—Medicinal preparations containing antigens or antibodies
- A61K2039/51—Medicinal preparations containing antigens or antibodies comprising whole cells, viruses or DNA/RNA
- A61K2039/525—Virus
- A61K2039/5256—Virus expressing foreign proteins
-
- C—CHEMISTRY; METALLURGY
- C12—BIOCHEMISTRY; BEER; SPIRITS; WINE; VINEGAR; MICROBIOLOGY; ENZYMOLOGY; MUTATION OR GENETIC ENGINEERING
- C12N—MICROORGANISMS OR ENZYMES; COMPOSITIONS THEREOF; PROPAGATING, PRESERVING, OR MAINTAINING MICROORGANISMS; MUTATION OR GENETIC ENGINEERING; CULTURE MEDIA
- C12N2710/00—MICROORGANISMS OR ENZYMES; COMPOSITIONS THEREOF; PROPAGATING, PRESERVING, OR MAINTAINING MICROORGANISMS; MUTATION OR GENETIC ENGINEERING; CULTURE MEDIA dsDNA viruses
- C12N2710/00011—Details
- C12N2710/24011—Poxviridae
- C12N2710/24111—Orthopoxvirus, e.g. vaccinia virus, variola
- C12N2710/24134—Use of virus or viral component as vaccine, e.g. live-attenuated or inactivated virus, VLP, viral protein
-
- C—CHEMISTRY; METALLURGY
- C12—BIOCHEMISTRY; BEER; SPIRITS; WINE; VINEGAR; MICROBIOLOGY; ENZYMOLOGY; MUTATION OR GENETIC ENGINEERING
- C12N—MICROORGANISMS OR ENZYMES; COMPOSITIONS THEREOF; PROPAGATING, PRESERVING, OR MAINTAINING MICROORGANISMS; MUTATION OR GENETIC ENGINEERING; CULTURE MEDIA
- C12N2710/00—MICROORGANISMS OR ENZYMES; COMPOSITIONS THEREOF; PROPAGATING, PRESERVING, OR MAINTAINING MICROORGANISMS; MUTATION OR GENETIC ENGINEERING; CULTURE MEDIA dsDNA viruses
- C12N2710/00011—Details
- C12N2710/24011—Poxviridae
- C12N2710/24111—Orthopoxvirus, e.g. vaccinia virus, variola
- C12N2710/24141—Use of virus, viral particle or viral elements as a vector
- C12N2710/24143—Use of virus, viral particle or viral elements as a vector viral genome or elements thereof as genetic vector
Landscapes
- Health & Medical Sciences (AREA)
- Life Sciences & Earth Sciences (AREA)
- Chemical & Material Sciences (AREA)
- Organic Chemistry (AREA)
- General Health & Medical Sciences (AREA)
- Genetics & Genomics (AREA)
- Medicinal Chemistry (AREA)
- Zoology (AREA)
- Engineering & Computer Science (AREA)
- Immunology (AREA)
- Virology (AREA)
- Bioinformatics & Cheminformatics (AREA)
- Pharmacology & Pharmacy (AREA)
- Animal Behavior & Ethology (AREA)
- Public Health (AREA)
- Veterinary Medicine (AREA)
- Wood Science & Technology (AREA)
- Biochemistry (AREA)
- Microbiology (AREA)
- Gastroenterology & Hepatology (AREA)
- Proteomics, Peptides & Aminoacids (AREA)
- Epidemiology (AREA)
- General Engineering & Computer Science (AREA)
- Biophysics (AREA)
- Molecular Biology (AREA)
- Biotechnology (AREA)
- Biomedical Technology (AREA)
- Toxicology (AREA)
- Nuclear Medicine, Radiotherapy & Molecular Imaging (AREA)
- General Chemical & Material Sciences (AREA)
- Chemical Kinetics & Catalysis (AREA)
- Mycology (AREA)
- Physics & Mathematics (AREA)
- Plant Pathology (AREA)
- Cell Biology (AREA)
- Oncology (AREA)
- Medicines Containing Material From Animals Or Micro-Organisms (AREA)
- Micro-Organisms Or Cultivation Processes Thereof (AREA)
- Medicines That Contain Protein Lipid Enzymes And Other Medicines (AREA)
Applications Claiming Priority (3)
| Application Number | Priority Date | Filing Date | Title |
|---|---|---|---|
| GBGB1816547.2A GB201816547D0 (en) | 2018-10-10 | 2018-10-10 | Oncolytic virus for the treatment of cancer |
| GB1816547.2 | 2018-10-10 | ||
| PCT/GB2019/052877 WO2020074902A1 (en) | 2018-10-10 | 2019-10-10 | Oncolytic vaccinia virus with modified b5r gene for the treatment of cancer |
Publications (1)
| Publication Number | Publication Date |
|---|---|
| KR20210102196A true KR20210102196A (ko) | 2021-08-19 |
Family
ID=64397608
Family Applications (1)
| Application Number | Title | Priority Date | Filing Date |
|---|---|---|---|
| KR1020217013839A Pending KR20210102196A (ko) | 2018-10-10 | 2019-10-10 | 암 치료를 위한 변형된 b5r 유전자를 갖는 종양용해 백시니아 바이러스 |
Country Status (7)
| Country | Link |
|---|---|
| EP (1) | EP3863669A1 (enExample) |
| JP (1) | JP7410139B2 (enExample) |
| KR (1) | KR20210102196A (enExample) |
| CN (1) | CN113453713A (enExample) |
| CA (1) | CA3123973A1 (enExample) |
| GB (1) | GB201816547D0 (enExample) |
| WO (1) | WO2020074902A1 (enExample) |
Families Citing this family (2)
| Publication number | Priority date | Publication date | Assignee | Title |
|---|---|---|---|---|
| CA3262167A1 (en) * | 2022-07-27 | 2024-02-01 | Astrazeneca Ab | COMBINATIONS OF RECOMBINATING VIRUSES EXPRESSING INTERLEUKIN-12 WITH PD-1/PDL1 INHIBITORS |
| WO2025184411A1 (en) | 2024-02-27 | 2025-09-04 | Calidi Biotherapeutics (Nevada), Inc. | Serum-resistant eev viruses and uses thereof |
Family Cites Families (3)
| Publication number | Priority date | Publication date | Assignee | Title |
|---|---|---|---|---|
| GB201405834D0 (en) * | 2014-04-01 | 2014-05-14 | Univ London Queen Mary | Oncolytic virus |
| US10888594B2 (en) * | 2016-05-30 | 2021-01-12 | National University Corporation Tottori University | Genetically engineered vaccinia viruses |
| TW201825674A (zh) * | 2016-09-09 | 2018-07-16 | 美商艾斯合顧問有限公司 | 表現雙特異性接合分子的溶瘤病毒 |
-
2018
- 2018-10-10 GB GBGB1816547.2A patent/GB201816547D0/en not_active Ceased
-
2019
- 2019-10-10 WO PCT/GB2019/052877 patent/WO2020074902A1/en not_active Ceased
- 2019-10-10 CN CN201980081698.5A patent/CN113453713A/zh active Pending
- 2019-10-10 CA CA3123973A patent/CA3123973A1/en active Pending
- 2019-10-10 KR KR1020217013839A patent/KR20210102196A/ko active Pending
- 2019-10-10 JP JP2021519114A patent/JP7410139B2/ja active Active
- 2019-10-10 EP EP19794623.9A patent/EP3863669A1/en active Pending
Also Published As
| Publication number | Publication date |
|---|---|
| JP2022502066A (ja) | 2022-01-11 |
| CA3123973A1 (en) | 2020-04-16 |
| JP7410139B2 (ja) | 2024-01-09 |
| US20210332384A1 (en) | 2021-10-28 |
| WO2020074902A1 (en) | 2020-04-16 |
| CN113453713A (zh) | 2021-09-28 |
| GB201816547D0 (en) | 2018-11-28 |
| EP3863669A1 (en) | 2021-08-18 |
Similar Documents
| Publication | Publication Date | Title |
|---|---|---|
| US20230293608A1 (en) | Oncolytic Vaccinia Virus | |
| EP3480307B1 (en) | New genetically-modified vaccinia virus | |
| US10888594B2 (en) | Genetically engineered vaccinia viruses | |
| JP2021527694A (ja) | 腫瘍溶解性ウイルスを用いた処置 | |
| JP6719642B2 (ja) | 組換えワクシニアウイルスおよびその使用 | |
| US11344589B2 (en) | Genetically engineered vaccinia viruses | |
| JP7410139B2 (ja) | 癌治療のための修飾b5r遺伝子を有する腫瘍溶解性ワクシニアウイルス | |
| US11932879B2 (en) | Mumps virus as a potential oncolytic agent | |
| US12509704B2 (en) | Oncolytic vaccinia virus with modified B5R gene for the treatment of cancer | |
| AU2023326730A1 (en) | Chimeric poxviruses | |
| WO2024026274A2 (en) | Virus-like vesicles (vlvs) based vaccines and methods of preventing, ameliorating, and/or treating covid-19 and/or hepatocellular carcinoma (hcc) | |
| HK40019406A (en) | Oncolytic vaccinia virus | |
| KR20250044313A (ko) | Pd-1/pd-l1 저해제와 인터루킨-12를 발현하는 재조합 바이러스의 조합물 | |
| HK40019406B (en) | Oncolytic vaccinia virus |
Legal Events
| Date | Code | Title | Description |
|---|---|---|---|
| PA0105 | International application |
Patent event date: 20210507 Patent event code: PA01051R01D Comment text: International Patent Application |
|
| PG1501 | Laying open of application | ||
| PA0201 | Request for examination |
Patent event code: PA02012R01D Patent event date: 20220923 Comment text: Request for Examination of Application |
|
| E902 | Notification of reason for refusal | ||
| PE0902 | Notice of grounds for rejection |
Comment text: Notification of reason for refusal Patent event date: 20250428 Patent event code: PE09021S01D |